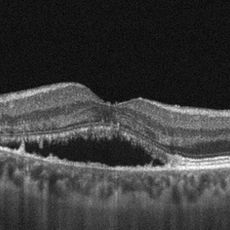

Il Prof. Vincenzo Scorcia è un chirurgo oftalmico specializzato in interventi avanzati per la correzione di patologie oculari.
Vanta oltre 12.000 interventi eseguiti come primo operatore, utilizzando tecniche all’avanguardia. Le sue principali aree di competenza chirurgica includono:
• Trapianto di cornea: specializzato in cheratoplastica lamellare anteriore e posteriore.
• Chirurgia del cheratocono: utilizza tecniche innovative per il trattamento di questa patologia corneale.
• Chirurgia della cataratta: esperto nell’uso di facoemulsificazione bimanuale per la rimozione della cataratta.
• Chirurgia del glaucoma: esperienza in interventi per la gestione chirurgica del glaucoma.
• Chirurgia vitreoretinica: competenze in tecniche sia ab-externo che ab-interno per il trattamento di patologie retiniche.
Il Prof. Scorcia opera principalmente presso lo Studio Oculistico di Catanzaro, CLIO e la Clinica Sanatrix di Roma.
LA CATARATTA

Cataratta bianca

IOL in camera anteriore
Il termine “cataratta” deriva dal greco (“catarréo”, discendere, cader giù) in quanto inizialmente si riteneva che l’opacamento della vista derivasse dalla “discesa di un velo” nell’occhio. In realtà oggi sappiamo che la cataratta è una opacizzazione, totale o parziale, del cristallino, lente naturale posta all’interno dell’occhio, dietro all’iride, che normalmente permette di mettere a fuoco sulla retina le immagini che osserviamo, a diverse distanze, attraverso un meccanismo muscolare dinamico noto con il nome di accomodazione.
Il cristallino è costituito da tre parti principali:
- nucleo (parte centrale)
- corticale anteriore e posteriore (parte periferica)
- capsula (involucro esterno)
La progressiva perdita di trasparenza del cristallino catarattoso riduce la quantità di luce che passa all’interno dell’occhio provocando una sintomatologia tipica caratterizzata da:
-
progressiva riduzione della nitidezza delle immagini
-
sensazione di annebbiamento
-
percezione dei colori meno vivida
-
elevata sensibilità alla luce (fotofobia)
-
aloni intorno alle sorgenti luminose
-
abbagliamento in caso di luci dirette e di forte intensità,
-
riduzione della visione soprattutto in condizioni di scarsa illuminazione (visione notturna)
-
variazione del difetto visivo preesistente e necessità di aggiornare spesso gli occhiali.
CLASSIFICAZIONE
Le diverse forme di cataratta possono essere classificate secondo vari principi; secondo il criterio eziologico, si possono distinguere forme congenite, già presenti in tenera età, e forme acquisite, che generalmente si manifestano nell’età adulta.
-
CATARATTA CONGENITA
Comprende forme di cataratta presenti alla nascita o che si manifestano entro i primi mesi di vita. Ancora oggi rappresenta la prima causa di cecità infantile nel mondo ed in più della metà dei casi colpisce entrambi gli occhi. Tra Le cause più frequenti ritroviamo, prime fra tutte, le infezioni contratte dalla madre in gravidanza (rosolia, parotite, varicella); fattori genetici (trasmissione ereditaria e anomalie cromosomiche come la S. di Down, trisomie 13 e 18, S. di Turner); raggi X; assunzione di farmaci in gravidanza (cortisonici, sulfamidici); alterazioni metaboliche - della madre (diabete, ipotiroidismo, carenze alimentari); - del feto; prematurità; alcune patologie oculari (vitreo primitivo iperplastico, microftalmo e retinopatia del prematuro). Se le opacità sono dense ed estese possono impedire il normale processo di sviluppo funzionale dell’apparato visivo, che avviene nei primi mesi di vita, determinando la comparsa del cosiddetto “occhio pigro” (ambliopia), oltre che strabismo e nistagmo. Molto spesso sono i genitori a riferire la presenza di un riflesso pupillare biancastro (leucocoria). Essendo di fondamentale importanza una diagnosi precoce, nel periodo perinatale deve essere eseguito il “test del riflesso rosso” per diagnosticare e trattare nel minor tempo possibile la cataratta congenita.
-
CATARATTA ACQUISITA
Le forme acquisite sono le più frequenti, riconoscono diverse cause e fattori predisponenti che condividono un meccanismo comune attraverso il quale concorrono a determinare una riduzione della trasparenza del cristallino, rappresentato da modificazioni nella composizione chimica della lente, e principalmente nell'ossidazione delle sue proteine. Fanno parte di questa categoria:
-
La cataratta “senile”, strettamente legata all’invecchiamento, è di gran lunga la forma più frequente; principale causa di cecità reversibile, è in continuo aumento considerando l’incremento dell’età media della popolazione mondiale. Infatti opacità più o meno isolate del cristallino, che interferiscono o meno con la visione, sono presenti in oltre il 60% dei soggetti con più di 70 anni. Il normale processo di invecchiamento del cristallino può essere influenzato da diversi fattori quali predisposizione genetica individuale, stress ossidativo, raggi UV, alcool e fumo. Si manifesta con una progressiva riduzione del visus per lontano, a volte accompagnato da un miglioramento della visione per vicino.
-
Cataratta associata a patologie sistemiche (es. diabete mellito, dermatite atopica, sclerodermia…),
-
Cataratta secondaria all’uso di farmaci (corticosteroidi, amiodarone…)
-
Cataratta traumatica: di solito interessa un solo occhio (monoculare); può essere secondaria a traumi contusivi sul bulbo oculare, ferite perforanti o a radiazioni UV o ionizzanti
-
Cataratta associata a patologie oculari quali uveite posteriore, miopia elevata, distrofie retiniche ereditarie.
Seguendo un criterio morfologico, in base alla localizzazione dell’opacizzazione nel cristallino possiamo distinguere:
-
cataratta corticale
-
cataratta nucleare
-
cataratta sottocapsulare anteriore e posteriore
Mentre in base al grado di opacità si distinguono:
-
cataratta immatura o iniziale
-
cataratta matura
-
cataratta ipermatura
-
cataratta bianca, intumescente e morgagnana.
Il decorso della cataratta nella maggior parte dei casi, non è prevedibile anche se normalmente ha una evoluzione lenta. Quando la cataratta riduce la qualità e la quantità visiva a tal punto da interferire con le normali attività quotidiane e lavorative, in rapporto alle esigenze del paziente, è richiesto l’intervento chirurgico. Procrastinare l’intervento aumenterebbe i rischi operatori legati ad una maggiore durezza del cristallino. In alcuni casi l’intervento dà luogo ad ulteriori vantaggi, contribuendo, per esempio, a ridurre la pressione intraoculare nei pazienti affetti da glaucoma.
INTERVENTO CHIRURGICO
L’asportazione del cristallino catarattoso comporta la perdita di un importante componente del sistema diottrico oculare. Mentre un tempo il difetto ipermetropico post operatorio veniva corretto con occhiali molto “spessi”, circa 12-13 diottrie, oggi è possibile inserire all’interno dell’occhio, un “cristallino artificiale” il cui potere viene calcolato, in base alle caratteristiche anatomiche e refrattive preoperatorie del singolo paziente, grazie all’esame biometrico che si avvale di strumenti e formule di calcolo sempre più sofisticati.
Generalmente l’intervento di cataratta viene eseguito in regime ambulatoriale e non è necessaria l’ospedalizzazione, dura circa 10-15 minuti, può essere eseguito in anestesia topica e/o locale, mediante la sola instillazione di un collirio anestetico oppure con delle iniezioni vicine all’occhio (anestesia peribulbare). Molto raramente è necessaria l’anestesia generale (es. pazienti non collaboranti). Attualmente esistono diversi metodi di rimozione della cataratta, la scelta della tecnica più appropriata per ogni singolo paziente è riservata al chirurgo. Nel corso degli anni, diverse metodiche chirurgiche sono state utilizzate, perfezionate ed evolute sintetizzandosi nella tecnica chirurgica attualmente più diffusa e praticata, la “facoemulsificazione”. Tale tecnica viene definita “mininvasiva” in quanto prevede delle “microincisioni” corneali (1,8-2,2 mm) che oltre alla ridotta invasività chirurgica consentono una maggiore sicurezza intra e post operatoria riducendo al minimo il traumatismo oculare, l’infiammazione e il rischio infettivo post chirurgico; nella maggior parte dei casi non è necessaria nessuna sutura, con conseguente riduzione dell’astigmatismo indotto chirurgicamente e una più rapida riabilitazione visiva. Lo strumento utilizzato, detto facoemulsificatore (da “pachos” lente), da cui il nome della tecnica, è composto da una sonda dotata di una punta sottile (da 1.8 a 2.5 mm di diametro) in grado di produrre ultrasuoni, che vibrando ad altissima frequenza consentono di frantumare il cristallino opaco in piccolissimi frammenti che a loro volta sono facilmente aspirati mediante un sistema automatico di irrigazione ed aspirazione continui. Dopo la rimozione della parte centrale, più dura, della cataratta, la corticale più periferica e “morbida”, viene rimossa con la sola aspirazione, mentre la maggior parte dell’involucro esterno del cristallino (la capsula) viene lasciata integra in quanto servirà ad accogliere il cristallino artificiale, mantenendo le condizioni anatomiche naturali dell’occhio. Il cristallino rimosso viene infatti sostituito da una “lente artificiale” - IOL- “Intra Ocular Lens” introdotta nell’occhio attraverso una speciale siringa (iniettore). La IOL non provoca reazioni di rigetto o allergia. È costituita da materiale di durata illimitata e non richiede cure o manutenzione. L’aspetto estetico è del tutto identico a quello naturale.
FEMTOLASER
Il laser a femtosecondi o femtolaser rappresenta una tecnologia di recente applicazione nell’intervento di cataratta. Rispetto alla chirurgia tradizionale non prevede l’impiego del bisturi, comportando un minor trauma per i tessuti oculari e garantendo una guarigione più rapida. Il raggio laser prodotto, grazie al rilascio di energia di brevissima durata (miliardesimo di secondo), è in grado di creare tagli estremamente precisi nel punto esatto in cui viene focalizzato. Il femtolaser può essere utilizzato per migliorare la sicurezza e la precisione dell’intervento permettendo di ottimizzare e standardizzare alcuni dei passaggi chirurgici più delicati quali:
-
Incisioni corneali: permette di eseguire gli accessi corneali monitorandone estensione e profondità.
-
Capsuloressi: consente di effettuare un’apertura centrata e simmetrica dell’involucro anteriore (capsula anteriore) del cristallino.
-
Frammentazione del cristallino in piccoli segmenti per una rimozione più efficace, riducendo quasi completamente l’uso di ultrasuoni e il conseguente riscaldamento dei tessuti oculari.
Tuttavia, in alcuni casi quali cataratte evolute o molto dure, presenza di opacità o irregolarità corneali e scarsa dilatazione pupillare, la tecnica tradizionale rimane il gold standard.
COMPLICANZE
Nonostante l’intervento di cataratta sia considerato uno dei più sicuri ed efficaci non è comunque scevro da complicanze. Le più frequenti sono rappresentate dalla rottura della capsula posteriore, un inconveniente in corso di intervento, che può determinare lo scivolamento di frammenti di cataratta nel corpo vitreo, liquido gelatinoso contenuto nel bulbo oculare, e rendere necessarie procedure chirurgiche aggiuntive (vitrectomia anteriore) e dall’infezione delle strutture interne dell’occhio (endoftalmite post-operatoria) dovuta a germi patogeni che possono entrare nel bulbo durante o dopo l’intervento. Tra gli effetti indesiderati nel periodo successivo all’operazione i più frequenti sono:
-
arrossamenti occasionali dell’occhio, bruciore, sensazione di “corpo estraneo”
-
lacrimazione per alterata distribuzione del film lacrimale
-
fastidio dovuto alla differenza di visuale fra l’occhio operato e quello non operato
-
temporaneo edema corneale
-
temporaneo aumento di pressione dell’occhio operato
CATARATTA SECONDARIA
In alcuni casi, può verificarsi nei mesi o negli anni successivi all’intervento, un’opacizzazione della capsula posteriore (involucro più esterno del cristallino che serve da supporto al nuovo cristallino artificiale impiantato) che va incontro ad un progressivo processo di fibrosi, provocando un nuovo annebbiamento della visione. Questo fenomeno viene indicato comunemente, anche se impropriamente, “cataratta secondaria”.
Il trattamento consiste nel realizzare una capsulotomia posteriore cioè un’apertura della capsula posteriore. L’intervento si avvale dell’utilizzo di un particolare tipo di laser (Yag Laser), in grado di praticare piccolissime incisioni, similmente ad un bisturi ad altissima precisione, senza la necessità di inserire all’interno dell’occhio nessuno strumento chirurgico. Il raggio laser viene focalizzato sulla superficie posteriore della capsula opacizzata per creare una piccolissima apertura, liberando nuovamente l’asse ottico e ripristinando una visione chiara e nitida. Prima dell’intervento, la superficie dell’occhio viene trattata con un collirio anestetico. Il trattamento non è invasivo, è assolutamente indolore, viene effettuato in modalità ambulatoriale e dura solo pochi secondi.
IOL (lenti intraoculari)
La chirurgia della cataratta, in questi ultimi anni, si è modificata profondamente trasformandosi in “chirurgia della cataratta refrattiva”, che va oltre la semplice eliminazione dell’opacità del cristallino; infatti, oggi il raggiungimento dell’emmetropia (assenza di difetti di vista) e l’indipendenza dagli occhiali è diventato uno degli obiettivi primari da raggiungere con questa chirurgia che ha portato allo sviluppo delle cosiddette "Premium IOLs", ossia lenti intraoculari customizzate in grado di andare oltre la semplice correzione del difetto sferico.
La correzione di eventuali difetti visivi, quali miopia ed ipermetropia, si ottiene a seguito di una serie di esami accurati, finalizzati a determinare il potere del cristallino artificiale che andrà ad eliminare gran parte del vizio refrattivo preesistente
La vista dopo l’intervento chirurgico dipende da una scelta consapevole della lente intraoculare che più si adatta alle proprie esigenze. Infatti attualmente in commercio esistono vari tipi di IOL che differiscono per diverse proprietà come la forma, le dimensioni, il materiale, l’angolazione delle anse, il contenuto di acqua, etc. di seguito alcuni esempi.
-
LENTI INTRAOCULARI STANDARD “MONOFOCALI”: sono progettate per ottenere un solo punto di messa a fuoco, solitamente si sceglie la distanza per lontano, lasciando all’occhiale la correzione del difetto per vicino. Consentono quindi, solo la correzione del difetto sferico. Tuttavia, in condizioni di basso contrasto o visione notturna la qualità della visione potrebbe non essere ottimale.
-
LENTI INTRAOCULARI TORICHE: Le IOL toriche, attualmente, rappresentano una delle soluzioni migliori per la correzione dell’astigmatismo, in quanto hanno un target refrattivo postoperatorio più prevedibile e possono correggere anche un astigmatismo di grado elevato; correttamente posizionata all’interno dell’occhio la lente compensa la distorsione della cornea, permettendo l’indipendenza degli occhiali nella visione per lontano nel postoperatorio. Le IOL toriche sono identiche a quelle monofocali, con l’unica differenza che hanno un orientamento preciso da rispettare; i pazienti candidati all’impianto di una IOL torica devono essere sottoposti ad una attenta valutazione diagnostica preoperatoria per una valutazione precisa del valore e dell’asse dell’astigmatismo corneale. È necessaria in fase pre o intraoperatoria la marcatura dell’asse stesso sul quale orientare la IOL; così durante l’intervento la IOL viene allineata con cura per evitare errori refrattivi.
-
LENTI INTRAOCULARI MULTIFOCALI: La IOL multifocale è progettata per ottenere un range di visione funzionale completo (vicino, intermedio, lontano) permettendo la messa a fuoco contemporanea di immagini poste a diversa distanza. Attualmente sono disponibili diverse tipologie di IOL multifocali, che differiscono fondamentalmente sul principio ottico che ne garantisce la multifocalità. Distinguiamo due tipi principali:
-
IOL multifocali refrattive: presentano zone, generalmente anulari, di potere refrattivo diverso che consentono di avere fuochi appropriati per vicino, per lontano e per la media distanza. L’energia luminosa dell’oggetto viene divisa in due o più fuochi principali in modo da ottenere immagini nitide alle distanze volute. Si ottengono più immagini di uno stesso oggetto ma una sola è a fuoco. Sono influenzate dal diametro pupillare, con disturbi soprattutto nelle attività o nella guida notturne.
-
IOL multifocali diffrattive: presentano una superficie anteriore liscia di tipo refrattivo utilizzata per correggere il difetto di focalizzazione per lontano ed una superficie posteriore diffrattiva, che presenta anelli concentrici che creano microscopici scalini (la cui altezza è compresa nell’ambito della lunghezza d’onda della luce), sfruttando il principio fisico della diffrazione per creare un secondo punto di messa a fuoco più anteriore, per la visione da vicino. Sono state recentemente perfezionate con le ottiche apodizzate: gli scalini diffrattivi sono modulati con una precisa riduzione dell'altezza dal centro alla periferia. Consentono una buona qualità visiva per lontano, e per vicino, meno alle distanze intermedie. Il vantaggio delle ottiche di tipo diffrattivo è che tutte le porzioni della lente contribuiscono alla creazione di entrambi i fuochi e quindi, a differenza delle lenti basate sull’ottica refrattiva, le variazioni del diametro pupillare non influiscono significativamente sul loro funzionamento. La presenza degli anelli diffrattivi può causare abbagliamento e aloni intorno alle fonti di luce.
Sono disponibili anche lenti miste Diffrattive/rifrattive e IOL multifocali TORICHE, per correggere contemporaneamente presbiopia e astigmatismo, oltre all’eventuale difetto sferico presente.
-
LENTI INTRAOCULARI ACCOMODATIVE: Attraverso un particolare forma della lente sembrano ripristinare il meccanismo naturale della messa a fuoco per vicino che si perde con l’età; sono lenti monofocali che cercano di riprodurre l’accomodazione naturale sfruttando il cambiamento della posizione della lente all’interno del sacco o un movimento dell’ottica grazie ad una particolare forma della lente stessa quando si contrae il muscolo ciliare. In questo modo riescono a mantenere una sola zona di fuoco per volta consentendo di eliminare alcuni fastidi, quali aloni e bagliori, tipici delle IOL multifocali ma la visione da vicino è meno precisa rispetto a queste ultime.
CHERATITE ERPETICA
La malattia oculare erpetica è una patologia complessa che rappresenta la seconda causa di cecità corneale nei paesi industrializzati.
L’ herpes simplex virus (HSV), appartenente alla famiglia degli Herpesviridae, è l’agente eziologico più comune nella cheratite virale ma possono essere coinvolti anche il virus Varicella Zoster (VZV), il Citomegalovirus (CMV) ed il virus di Epstein Barr (EBV).
Si tratta di virus in grado di infettare le cellule nervose che danno un’infezione primaria (primo contatto che l’organismo ha con il paziente erpetico) e vanno in fase di latenza (stato “dormiente” che può durare anche anni) nei gangli nervosi; si possono riattivare e dare una recidiva in seguito a riduzione delle difese immunitarie legate all’età o iatrogene, febbre, stress, traumi chirurgici, esposizione a raggi ultravioletti, ecc.
Le manifestazioni cliniche più frequenti dell’infezione erpetica primaria oculare sono:
-
Lesioni vescicolari palpebrali che tendono ad ulcerarsi e guariscono formando lesioni crostose;
-
Congiuntivite follicolare acuta;
-
Cheratite erpetica che può coinvolgere tutti gli strati corneali.
L’infezione primaria del virus coinvolge in genere gli strati più superficiali della cornea, diffondendosi attraverso le vie nervose e manifestandosi a livello epiteliale sotto forma di “vescicola corneale”, “cheratite dendritica” o “ulcera a carta geografica”, associate a riduzione della sensibilità nell’area interessata;
L’infezione erpetica può, tuttavia, interessare anche gli strati più profondi determinando l’insorgenza della “cheratite stromale”, in cui la gran parte del danno è mediata dal sistema immunitario dell’organismo che nel tentativo di combattere il virus distrugge anche i propri tessuti.
È la forma clinica più frequente nei casi di malattia recidivante ed è responsabile di un rilevante calo visivo del paziente.
Quadri più complessi di tale infezione sono rappresentati dall’insorgenza di “cheratite neutrofica”, in cui le alterazioni dell’innervazione corneale indotte dal virus impediscono la riepitelizzazione e la protezione della superficie corneale; questo tipo di cheratite può essere aggravata dall’utilizzo cronico di cortisoni topici.
Infine l’infezione può coinvolgere l’endotelio corneale, “endotelite erpetica”, caratterizzata dalla comparsa del cosiddetto “edema corneale disciforme” (edema a forma di disco) o da opacità corneale diffusa (endotelite diffusa).
L’uveite erpetica anteriore è una complicanza dell’infezione in cui non solo la cornea, ma anche iride, trabecolato ed altre strutture oculari sono coinvolte dal processo infiammatorio; nei casi più gravi si può complicare con ipopion (raccolta di essudato purulento in camera anteriore) ed ipoema (raccolta di sangue in camera anteriore).
La cheratite erpetica è una tra le patologie oculari più difficili da curare, a causa della sua duplice origine (virale e immunologica) e dell’alto tasso di recidive che ne gravano la prognosi. La terapia è rappresentata da farmaci antivirali topici e sistemici, es. Aciclovir o Ganciclovir, che sono impiegati per arrestare la replicazione virale in corso d’infezione iniziale e per ridurre il tasso di recidive.
Le forme stromali, invece, sono trattate con terapia steroidea topica, associata sempre ad antivirali sistemici.
Le opacità corneali che nella maggior parte dei casi residuano dopo infezioni erpetiche provocano deficit visivi importanti; in tali casi l’unico trattamento è chirurgico, mediante cheratoplastica, con procedure che possono variare a seconda del caso clinico (cheratoplastica lamellare, cheratoplastica perforante, cheratoplastica a fungo, etc.). Tuttavia, a causa dell’alto rischio di recidiva e della neo-vascolarizzazione a livello del lembo trapiantato, spesso presente in questi casi, l’esito dell’intervento chirurgico può essere spesso solo transitorio.
CHERATOCONO
Il cheratocono è una distrofia della cornea bilaterale, progressiva, non infiammatoria, caratterizzata dal suo graduale sfiancamento (definito come “ectasia”); tale anomalia si manifesta generalmente in giovane età e porta a un progressivo calo del visus.
La sua frequenza è stimata intorno ad 1 caso su 2.000, anche se probabilmente tale valore è maggiore, considerando che in molti pazienti la diagnosi è occasionale; infatti, negli stadi iniziali l’unico segno può essere la presenza di un semplice astigmatismo.
L’origine è in parte sconosciuta, anche se esiste una componente genetica rilevante come dimostrato dall’alta incidenza della patologia all’interno della stessa famiglia.
Dal punto di vista ottico il cheratocono è rappresentato da un assottigliamento progressivo del tessuto corneale che provoca una deformazione asimmetrica della superficie corneale (in genere un astigmatismo miopico irregolare) che riduce progressivamente la capacità visiva.
La sua evoluzione è spesso poco prevedibile in quanto vi sono pazienti in cui la malattia progredisce rapidamente, nel giro di pochi mesi, mentre in altri il peggioramento è molto lento; inoltre, non è raro osservare forme di cheratocono molto lievi (definite “fruste”) che rimangono invariate per tutta la vita senza manifestare mai segni di progressione.
In molti casi questa evoluzione si può in osservare anche nello stesso paziente, che avverte una progressione dell’ectasia (e calo del visus) in un occhio, mentre il controlaterale resta stabile.
LA DIAGNOSI
La topografia corneale è l'esame d'elezione per la diagnosi e lo studio dell'evoluzione del cheratocono. Si tratta di uno strumento che analizza i dati derivati dalla riflessione di anelli luminosi concentrici (disco di Placido) proiettati sulla cornea e li trasforma in mappe colorate (topografiche) che ne descrivono la forma e la regolarità della superficie anteriore. Attraverso questo esame è possibile evidenziare tutte le alterazioni di riflessione della cornea e riconoscere anomalie, anche molto iniziali della curvatura corneale.
Il secondo esame fondamentale è rappresentato dalla pachimetria corneale (misurazione dello spessore centrale) che si ottiene con una sonda a ultrasuoni o con metodiche ottiche.
Una metodica recente è rappresentata dalla tomografia corneale con lampada rotante di Scheimpflug che consente un’analisi della cornea in tre dimensioni inclusa la superficie posteriore; questa metodica consente una diagnosi più precoce in caso di forme iniziali di cheratocono oltre che una pachimetria ottica in ogni singolo punto.
LA TERAPIA
Le terapie del cheratocono sono diverse e dipendono fondamentalmente dalla severità della patologia; la prima forma di terapia è puramente “ottica”, e consiste nella correzione dell’errore refrattivo indotto dal cheratocono. Nelle sue fasi iniziali, il difetto visivo generato dal cheratocono può essere corretto con occhiali o lenti a contatto morbide convenzionali. Negli stadi più avanzati della patologia, l’astigmatismo elevato ed irregolare indotto dalla deformazione può essere corretto solo parzialmente con occhiali e l’unico presidio ottico è rappresentato dall’applicazione di lenti a contatto rigide o semi-rigide gas-permeabili; tale soluzione è in grado di ottenere un recupero funzionale completo (10/10 o meglio).
Il secondo tipo di terapia rappresenta una forma di “profilassi” (intesa cioè a prevenire l’evoluzione della patologia verso gli stadi più severi) ed è rappresentata dal Cross-Linking Corneale.
L’ultima opzione terapeutica è costituita dall’intervento di trapianto di cornea (o cheratoplastica); tale procedura rappresenta l’unica alternativa per riabilitare la visione nei casi in cui la correzione del difetto con lenti a contatto non sia possibile, a causa dell’eccesiva curvatura della cornea, della presenza di cicatrici centrali o per l’insorgenza di fenomeni d’intolleranza (10-20%)
IL CROSS-LINKING CORNEALE
Il Cross-Linking corneale è una tecnica che utilizza l’applicazione di Riboflavina (Vitamina B2) in soluzione con destrano al 20% (uno zucchero) sulla superficie anteriore della cornea.
L’impregnazione di questa soluzione nel tessuto corneale e la successiva esposizione di raggi UVA (370 nm) ha come effetto finale un incremento della rigidità della cornea; il meccanismo fisico-chimico è rappresentato dall’attivazione di radicali liberi dell’ossigeno che mediante una desaminazione ossidativa del collagene induce la formazione di nuovi ponti molecolari intra-elicoidali e inter-fibrillari.
Il risultato ottenuto con il trattamento di Cross-Linking è di bloccare il cedimento e l’assottigliamento strutturale della cornea ed è indicato nelle patologie corneali caratterizzate dal progressivo sfiancamento del tessuto, come il cheratocono e l’ectasia post-chirurgia refrattiva ablativa (Lasik o PRK).
Sebbene alcuni pazienti sottoposti a questo trattamento possano ottenere una diminuzione della miopia o dell’astigmatismo corneale, tale procedura non ha come obiettivo la riduzione del difetto di vista ma la stabilizzazione della patologia.
Tuttavia, in molti casi l’appiattimento della superficie può migliorare la tolleranza all’uso della lente a contatto, che in tali pazienti rappresenta spesso l’unica possibilità terapeutica per raggiungere un visus adeguato.
Dal punto di vista chirurgico la procedura è relativamente semplice e non dolorosa: il paziente è posizionato solitamente sul lettino chirurgico e si instillano alcune gocce di collirio anestetico; si inserisce un blefarostato (una specie di molletta che evita la chiusura delle palpebre) e si rimuove l’epitelio corneale (lo strato cellulare superficiale che riveste la parte esterna della cornea) con una spatola dedicata, per un diametro di circa 9 mm.
Si applica il gel di riboflavina sulla cornea per 15-20 minuti, al fine di ottenere un’imbibizione completa del tessuto corneale; in seguito, si attiva l’apparecchio che emette i raggi UVA per 6 fasi da 5 minuti ciascuna, per un totale di 30 minuti.
La durata complessiva del trattamento è di circa 45 minuti ed è completamente indolore; al termine l’occhio viene medicato con colliri antibiotici e viene applicata una lente a contatto terapeutica che verrà rimossa dopo circa 4 giorni. Non è necessario praticare un bendaggio.
Esiste anche la possibilità di eseguire un trattamento che prevede la conservazione dell’epitelio (definito “epi-on”) che in genere è effettuato in cornee sottili con uno spessore inferiore ai 400 micron; in aggiunta, sono state recentemente introdotte sul mercato nuove metodiche in grado di rendere ancora più rapida l'esecuzione dell'intera procedura mantenendo inalterata la sicurezza ed efficacia della procedura.
Nei primi giorni dopo il trattamento, il paziente può avvertire sensazione di corpo estraneo e dolore per le prime 48 ore; la lente a contatto è rimossa dopo circa 4-5 giorni.
La visione è lievemente offuscata per i primi giorni e si stabilizza dopo circa un mese, durante il quale il paziente continua a somministrare terapia steroidea topica. Nel giro di qualche settimana si può riutilizzare l’occhiale o la precedente lente a contatto; eventuali variazioni del difetto di vista saranno valutate dopo circa tre mesi.
Chi può essere trattato con il Cross Linking
• Cheratoconi al I e II stadio con trasparenza corneale conservata, degenerazione marginale pellucida, ectasie post-trattamenti di chirurgia refrattiva.
• Lo spessore corneale nel punto più sottile non deve essere inferiore a 400 micron per il trattamento epi-off.
• Malattia in stato di progressione.
Quali esami eseguire:
La visita pre-operatoria deve essere eseguita previa sospensione dell’applicazione di lenti a contatto per circa 10 giorni. Il paziente è sottoposto a tutti gli esami di screening che accertano la diagnosi della patologia e l’assenza di eventuali controindicazioni al trattamento; tali esami includono: esame obiettivo del segmento anteriore, mappa corneale o tomografia del segmento anteriore, pachimetria ottica o a contatto, conta endoteliale, tonometria, esame del fondo oculare.
IL TRAPIANTO DI CORNEA (O CHERATOPLASTICA)
La Cheratoplastica Lamellare Anteriore Profonda (o DALK, dall’acronimo inglese per “Deep Anterior Lamellar Keratoplasty”) è una procedura chirurgica che prevede la rimozione dello stroma corneale fino alla membrana più interna (Membrana di Descemet). La DALK rappresenta il trattamento chirurgico di scelta per la maggior parte delle patologie corneali in cui l’endotelio è sano, come ad esempio il cheratocono, cicatrici superficiali e profonde o distrofie dello stroma corneale.
La DALK offre una serie di vantaggi teorici e pratici rispetto ad una procedura di cheratoplastica perforante. Il primo vantaggio è legato alla migliore e prolungata sopravvivenza del lembo trapiantato. Nelle procedure convenzionali a tutto spessore circa il 20% dei trapianti va incontro a scompenso tardivo a causa di reazioni di rigetto immunologico o riduzione cronica delle cellule endoteliali; nella DALK, invece, tale rischio è teoreticamente assente poiché l’endotelio del ricevente è conservato. Nella maggior parte delle procedure lamellari, l’intervento è eseguito in condizioni di bulbo chiuso, riducendo in maniera significativa il rischio di complicanze intraoperatorie maggiori (emorragia sovracoroideale). L’astigmatismo ad un anno dall’intervento è inferiore a quello registrato allo stesso intervallo di tempo dopo PK. I tempi di cicatrizzazione e guarigione sono ridotti, così come la necessità di prolungare per tempi lunghi la terapia topica cortisonica.
I risultati visivi associati a procedure di cheratoplastiche lamellari sono simili a quelli ottenuti dopo PK solo in caso di rimozione completa dello stroma corneale ed esposizione della membrana di Descemet; in caso di dissezioni stromali profonde, ma non complete, l’acuità visiva può essere ridotta (soprattutto in termini di sensibilità al contrasto) a causa di opacità dell’interfaccia creata fra cornea donatrice o ricevente; in tali situazioni i tempi di recupero possono allungarsi sensibilmente, con possibili miglioramenti della qualità della visione ottenibili anche a distanza di 2 o 3 anni dall’intervento.
L’unico limite di tali procedure è legato alla complessità della tecnica, che richiede lunghi tempi d’apprendimento e in alcuni casi anche lunghi tempi intraoperatori; per tale motivo molti chirurghi preferiscono tuttora eseguire una cheratoplastica perforante.
DALK: Tecniche
In letteratura sono state descritte numerose tecniche alternative per eseguire una DALK. Uno dei primi metodi descritti è quello di rimuovere lo stroma anteriore strato-per-strato fino a raggiungere gli spazi profondi o la membrana di Descemet. Sebbene esistano diversi approcci, la tecnica base consiste nei seguenti passaggi:
Occhio ricevente. Un’incisione circolare a parziale spessore (circa 2/3) è ottenuta mediante l’uso di un trapano a suzione; gli strati corneali più superficiali sono rimossi mediante l’uso di una lama circolare mantenendo un piano parallelo alla superficie endoteliale. Gli strati corneali sono separati mediante l’iniezione di fluido o aria usando un ago o cannula da 25/27 gauge.
• Iniezione di aria intrastromale. Consiste nell’iniezione di aria mediante ago o cannula connessi a una siringa di 2,5 cc per ottenere lo sbiancamento dello stroma corneale (enfisema) che semplifica la rimozione manuale degli strati della cornea.
• Idro-delaminazione. Dopo un’iniziale trapanazione parziale del letto ricevente, s’inietta BSS (balanced salt solution) in una piccola tasca stromale in precedenza ricavata; le fibre collagene s’imbibiscono facilitando la loro rimozione manuale.
• Dissezione con viscoelastico. Dopo iniziale trapanazione del letto ricevente, s’inietta con una cannula smussa una sostanza viscoelastica (sodio ialuronato) fra le lamelle corneali centrali il più possibile vicino alla membrana di Descemet; tale sostanza facilita la rimozione degli strati profondi.
• Big bubble. È la tecnica più diffusa, nota con il termine “Big Bubble” a causa dell’aspetto che la membrana di Descemet assume qualora si ottenga il suo distacco dallo stroma profondo.
Complicanze
La complicanza più frequente nella DALK è la perforazione della membrana di Descemet e la penetrazione in camera anteriore. Rotture o perforazioni si possono presentare nel 10-30% dei casi e la loro gestione dipende dalla grandezza e dalla fase intraoperatoria in cui si realizzano; tuttavia nella maggior parte dei casi la procedura è portata al termine senza la necessità di convertire in una PK. Evenienza più rara è l’ischemia iridea con presenza di pupilla fissa dilatata, nota come Sindrome di Urrets-Zavalia.
CHERATOPLASTICA
Cheratoplastica è il termine tecnico con il quale s’identifica genericamente il trapianto di cornea e consiste nella sostituzione della cornea del paziente (ricevente), affetta da patologia, con una cornea sana (donatrice).
Il fine del trapianto può essere quello di migliorare la visione del paziente (Ottico), preservare l’integrità della cornea danneggiata (Strutturale) o curare un’infezione corneale sostituendone il tessuto infetto (Terapeutico).
Esistono diversi tipi di cheratoplastica a seconda che la cornea del paziente venga sostituita a tutto spessore (Cheratoplastica Perforante) o parzialmente (Cheratoplastica Lamellare).
Nell’intervento di cheratoplastica lamellare anteriore un passaggio chiave è rappresentato dalla preparazione della cornea del ricevente nella quale è rimossa una porzione di stroma di spessore e diametro variabili, a seconda del tipo di cheratoplastica, e sostituita con una porzione di cornea donatrice di uguale spessore e diametro. Per effettuare la sostituzione, infatti, le due cornee devono essere adeguatamente tagliate (dissezione) al fine di ottenere una sovrapposizione quanto più precisa possibile tra la cornea donatrice e la cornea ricevente residua.
Con l’avanzare della tecnologia, la tecnica di dissezione della cornea donatrice/ricevente si è evoluta:
-
Dissezione pneumatica (tecnica Big-Bubble);
-
Dissezione manuale;
-
Dissezione con Microcheratomo: una delle principali innovazioni tecnologiche nelle cheratoplastiche lamellari in quanto permette di migliorare l’interfaccia ottica ed offre la possibilità di utilizzare diverse testine per rimuovere e/o aggiungere lamelle corneali di diverso spessore.
-
Dissezione con Laser a Femtosecondi (Femtolaser): che consente di effettuare tagli di estrema precisione, accuratezza e riproducibilità, permettendo una perfetta apposizione dei due lembi del trapianto.
Cheratoplastica Perforante (PK): Consiste nella sostituzione a tutto spessore della porzione centrale della cornea affetta con una cornea donatrice sana. Nello specifico, la cornea ricevente viene trapanata a tutto spessore creando un foro di circa 8 mm di diametro nella zona centrale. Il lembo donatore viene punzonato alle stesse dimensioni, adattato al letto ricevente e suturato allo stesso con Nylon 10-0, utilizzando suture che possono variare da singoli punti staccati a suture continue o una combinazione delle due. Con lo svilupparsi delle tecniche lamellari la cheratoplastica perforante è rimasta indicata quasi esclusivamente per le opacità corneali a tutto spessore. Inoltre, nonostante la semplicità della tecnica, essa presenta comunque rischi intraoperatori (emorragia espulsiva) e complicanze tardive (astigmatismo elevato e irregolare, rigetto immunologico, scompenso tardivo del lembo, etc.) che ne riducono l’impiego a favore di tecniche lamellari più conservative e selettive.
Un’evoluzione della PK è la Cheratoplastica a Fungo (Mushroom-PK), indicata per le opacità stromali centrali a tutto spessore con endotelio generalmente sano e in tutte le condizioni caratterizzate da neo-vascolarizzazione corneale. Infatti, essa consiste nell’incisione circolare mediante trapano o laser-assistita di un’area di stroma superficiale al di sotto della quale, dopo dissezione manuale dello stroma, viene effettuata una nuova incisione circolare di diametro inferiore. Il bottone corneale centrale così creato viene quindi escisso. La cornea donatrice viene quindi divisa in due sezioni anteriore e posteriore mediante l’utilizzo del microcheratomo e queste lamelle vengono punzonate in modo da adattarsi perfettamente alle dimensioni del letto precedentemente preparato.
Le caratteristiche di tale procedura consistono nelle buone proprietà ottiche della lamella anteriore di ampio diametro (8.75-9.00 mm) e nel ridotto rischio di scompenso endoteliale a lungo termine garantito da un bottone interno di dimensioni ridotte (5.5-6.5 mm). Così si superano molti dei limiti della PK.
Cheratoplastiche Lamellari: consistono nella sostituzione di alcuni strati corneali della cornea ricevente con i corrispondenti strati della cornea donatrice.
Esse si suddividono in base allo strato da sostituire in Cheratoplastiche Anteriori e Posteriori.
Le forme anteriori possono a loro volta essere ulteriormente distinte in forme superficiali (Superficial Anterior Lamellar Keratoplasty, SALK) e forme profonde (Deep Anterior Lamellar Keratoplasty, DALK). Rispetto alla cheratoplastica perforante queste procedure presentano i vantaggi di una maggiore selettività e ripetibilità ed un rischio di rigetto immunologico sensibilmente ridotto.
Le cheratoplastiche posteriori sono indicate nei casi in cui la funzione di pompa dell’endotelio, che rimuove attivamente l’acqua dallo stroma corneale, venga meno portando a progressiva imbibizione corneale e perdita di trasparenza. Pertanto, le principali indicazioni alle cheratoplastiche posteriori sono le patologie che compromettono la funzionalità dell’endotelio come la distrofia endoteliale di Fuchs, la cheratopatia bollosa in pazienti pseudofachici, o ancora le distrofie endoteliali congenite (CHED e PPD). Le due forme di cheratoplastica posteriore sono la DSAEK (Descemet Stripping Automated Endothelial Keratoplasty) e la DMEK (Descemet Membrane Endothelial Keratoplasty), che si distinguono tra loro per lo spessore della lamella trapiantata che nel caso della DSAEK comprende oltre al complesso Descemet-Endotelio anche un sottile strato di stroma profondo.
La SALK (Cheratoplastica Lamellare Anteriore Superficiale) è una tecnica indicata per tutte le patologie corneali caratterizzate da opacità sub-epiteliali o stromali superficiali (haze post-chirurgia refrattiva con laser ad eccimeri, distrofie della Membrana di Bowman, distrofia granulare o a lattice, etc.). La procedura consiste nella rimozione dal ricevente di una lamella anteriore, di spessore compreso tra i 130 ed i 250 µm e di circa 9 mm di diametro, mediante microcheratomo e la sostituzione con una lamella preparata da cornea donatrice, montata su camera artificiale di 130 µm spessore e di identico diametro. Il lembo è adattato sul letto ricevente e al fine di evitare il rischio di un dislocamento del lembo nell’immediato postoperatorio si posiziona una sutura a sopraggitto (rimossa dopo 6-7 giorni).
I vantaggi sono rappresentati da una rapida riabilitazione visiva con una refrazione stabile già un mese dopo l’intervento, un astigmatismo topografico minimo garantito dalla mancanza di suture e l’assenza di rigetto immunologico endoteliale, non essendo stato quest’ultimo interessato dalla procedura.
La DALK (Cheratoplastica Lamellare Anteriore Profonda) è una procedura chirurgica che prevede la rimozione dello stroma corneale fino alla membrana più interna (Membrana di Descemet) e la sostituzione dello stesso con quello della cornea donatrice.
Essa rappresenta il trattamento chirurgico di scelta per la maggior parte delle patologie corneali in cui l’endotelio è sano, come ad esempio il cheratocono, le cicatrici superficiali e profonde o le distrofie dello stroma corneale.
La tecnica base consiste in un’incisione circolare a spessore parziale di diametro variabile ottenuta mediante l’uso di un trapano a suzione o del femtolaser (Femto-Dalk); gli strati corneali più superficiali sono rimossi mediante l’uso di una lama circolare mantenendo un piano parallelo alla superficie endoteliale. Gli strati corneali possono essere separati mediante l’iniezione con un ago o cannula di:
-
che va a distaccare lo stroma profondo dalla membrana di Descemet creando una vera e propria bolla (tecnica “Big Bubble”).
-
(balanced salt solution) nell’Idro-delaminazione che va ad imbibire le fibre collagene dello stroma rendendo la loro rimozione più semplice.
-
Viscoelastico (Sodio Ialuronato) che facilita la rimozione delle lamelle corneali.
Tra queste, la tecnica di dissezione più diffusa è la Big Bubble. La cornea donatrice viene punzonata alle stesse dimensioni, adattata al letto ricevente e suturata in Nylon 10-0.
I vantaggi di questa procedura rispetto alla cheratoplastica perforante consistono nella migliore sopravvivenza del lembo trapiantato, grazie alla conservazione dell’endotelio del ricevente, nel minor astigmatismo postoperatorio e nella ridotta incidenza di complicanze intraoperatorie maggiori (emorragia sovracoroideale).
Generalmente i risultati visivi sono sovrapponibili a quelli della PK, eccettuati i casi di mancata rimozione completa dello stroma corneale che potrebbe ridurre l’acuità visiva e rallentare il tempo di recupero postoperatorio.
La complicanza più frequente nella DALK è la perforazione della membrana di Descemet e la penetrazione in camera anteriore, che, a seconda della grandezza della perforazione e della fase intraoperatoria in cui avviene, può essere gestita nella maggioranza dei casi senza necessità di conversione in una PK. Evenienza più rara è l’ischemia iridea con presenza di pupilla fissa dilatata, nota come Sindrome di Urrets-Zavalia.
La DSAEK (Descemet Stripping Automated Endothelial Keratoplasty) è la tecnica di scelta nel trattamento dello scompenso corneale ed ha come finalità la sostituzione dell’endotelio corneale. La procedura consiste nel riempire la camera anteriore con aria e procedere alla rimozione con un uncino smusso del complesso endotelio-Descemet del ricevente in un singolo foglietto (stripping) lungo un’area circolare di circa 8 mm. La lamella corneale donatrice viene preparata rimuovendo lo stroma anteriore mediante microcheratomo con testina da 300-400 µm. La lamella posteriore così ottenuta viene poi punzonata per ottenere lo stesso diametro dell’area di endotelio rimosso dal ricevente ed inserita mediante apposito glide attraverso un tunnel nasale clear-cornea. Sotto il flusso continuo dell’irrigazione, la lamella donatrice si apre spontaneamente. Sia il tunnel clear-cornea che l’entrata laterale possono essere suturate con nylon 10-0 e la camera anteriore è totalmente riempita con aria.
I vantaggi di questa tecnica rispetto alla PK consistono nel rapido recupero funzionale, grazie all’assenza di cicatrici stromali centrali, in una ridotta incidenza di complicanze intraoperatorie maggiori, essendo una chirurgia a bulbo “chiuso” ed in una modifica minima dell’astigmatismo corneale preoperatorio.
Le complicanze postoperatorie sono rappresentate dal fallimento precoce del lembo (scompenso primario) che si manifesta con l’assenza di trasparenza corneale dovuta ad insufficiente vitalità del lembo stesso ed in particolare dell’endotelio. Sebbene la DSAEK sia una tecnica selettiva di trapianto corneale, la presenza di un endotelio proveniente da donatore la espone a complicanze comuni alla cheratoplastica perforante quali il rigetto immunologico e lo scompenso tardivo del lembo.
Una variante della DSAEK è l’UT-DSAEK (UltraThin-DSAEK) che è caratterizzata da uno strato di stroma profondo più sottile, con lembi di spessore inferiore ai 100µm per cercare di migliorare ulteriormente i risultati visivi.
La DMEK (Descemet Membrane Endothelial Keratoplasty) consiste nello stripping del solo complesso endotelio-Descemet del ricevente e la sostituzione dello stesso con il complesso endotelio-Descemet del donatore adeguatamente preparato. Essa condivide le indicazioni con la DSAEK, a differenza della quale, andando a rimpiazzare il solo endotelio con la rispettiva membrana di Descemet, dovrebbe avere un miglior risultato visivo in quanto si evita la creazione di interfacce stromali. I limiti della tecnica sono quelli di una più difficile curva di apprendimento e di una più difficile iniezione del lembo donatore, che essendo più sottile potrebbe non dispiegarsi correttamente o non aderire correttamente alla cornea ricevente (scompenso primario). La DMEK condivide con la DSAEK le complicanze post-operatorie quali il rigetto immunologico e lo scompenso tardivo del lembo.
DEFICIT STAMINALI
e DRY EYE
Le cellule staminali corneali sono localizzate nelle palizzate di Vogt a livello del limbus sclero-corneale. Esse presiedono alla differenziazione e proliferazione delle cellule epiteliali corneali e sono dei veri e propri centri germinativi da cui traggono origine le cellule che andranno a ricoprire e proteggere la cornea.
Lo stato di salute delle cellule staminali limbari è determinante nel mantenimento della salute epiteliale e nei processi rigenerativi delle lesioni corneali epiteliali.
Queste ultime, infatti, possono essere divise in base al coinvolgimento limbare in: lesioni epiteliali a limbus intatto o con coinvolgimento limbare parziale o totale.
All’aumentare del danno limbare si riduce la probabilità di restitutio ad integrum del difetto epiteliale, in quanto una minor popolazione di cellule staminali riuscirà a migrare per ripristinare l’integrità epiteliale. È dunque intuitivo che un qualsiasi tipo di lesione che interessi in toto o in gran parte il limbus esiterà in un deficit di cellule staminali limbari (LSCD).
La LSCD può essere:
-
Primaria: aniridia, eritrocheratodermia congenita, cheratiti associate a sindromi endocrine multiple, etc.
-
più comune, provocata da ustioni termiche o chimiche (alle quali possono associarsi patologie della congiuntiva e delle palpebre, Sindrome di Stevens-Johnson, Pemfigoide oculare cicatriziale (OCP) e chirurgie multiple.
La LSCD può essere totale o parziale se è coinvolto solo un settore.
La clinica è caratterizzata dai sintomi legati all’infiammazione cronica.
Fotofobia, lacrimazione, rossore sono alcuni dei sintomi più comuni, tuttavia la sintomatologia può differire sensibilmente in funzione della causa scatenante. Nei casi avanzati la compromissione delle superficie oculare porta allo sviluppo di quadri clinici severi che vanno dalla neo-vascolarizzazione corneale fino alla perforazione.
La diagnosi è indirizzata dai reperti clinici e confermata attraverso la citologia ad impressione che evidenzia l’inusuale presenza sulla superficie corneale delle “goblet cells” contenenti epitelio congiuntivale.
L’approccio terapeutico nei casi di presentazione acuta, come le ustioni chimiche, prevede l’allontanamento dell’agente chimico tramite irrigazione con soluzione salina sterile ed eventuale escissione di tessuto congiuntivale e sottocongiuntivale impregnato di particolato. Segue una iniziale terapia conservativa con colliri antibiotici, sostituti lacrimali e nell’immediatezza steroidi topici da interrompere al primo segno di melting corneale.
Nei casi di deficit ormai consolidato si distinguono forme di deficit parziale, in cui la semplice rimozione del panno corneale creatosi può migliorare il quadro clinico pur essendo sufficiente solo in una piccola percentuale di casi, e forme totali la cui terapia è il trapianto di limbus associato o meno a successivo intervento di cheratoplastica.
Il trapianto può essere autologo, se il tessuto proviene dall’occhio sano controlaterale, o eterologo se proveniente da parente o da cadavere; la differenza fondamentale è nel rischio di rigetto (virtualmente assente nel primo caso, elevata nel secondo).
Per tale motivo, in caso di trapianto eterologo è fondamentale che i pazienti siano sottoposti a intensi e prolungati cicli di terapia immunosoppressiva al fine di aumentare le probabilità di sopravvivenza del trapianto.
OCCHIO SECCO ("Dry eye")
La produzione continua di lacrime ed il loro drenaggio attraverso le vie lacrimali è fondamentale per il mantenimento dell’integrità della superficie corneale; tale meccanismo fisiologico, infatti, presiede alla guarigione delle ferite e alla protezione contro le infezioni.
Il film lacrimale è composto da tre strati: uno esterno, oleoso o lipidico che previene la rapida evaporazione della componente acquosa (che rappresenta il secondo strato); il terzo e più profondo è quello mucoso che ha la funzione di favorire la diffusione del film sulla superficie. Con l’invecchiamento vi è una naturale diminuzione della quantità di lacrime prodotte con possibile alterazione anche qualitativa dello strato lipidico e mucoso.
La sindrome dell’occhio secco (Dry Eye) è una patologia del film lacrimale che risulta incapace di mantenere la superficie corneale anteriore lubrificata, a causa di una ridotta produzione fisiologica di lacrime o di una loro eccessiva evaporazione.
L’occhio secco è più comune nel sesso femminile ed in età avanzata, soprattutto dopo la menopausa. Esso può essere legato a patologie oculari coesistenti (disfunzione delle ghiandole di Meibomio, blefariti e patologie congiuntivali), malattie sistemiche (artrite reumatoide, Sindrome di Sjögren) o può essere provocato dall’assunzione di alcuni farmaci (antidepressivi, antistaminici). Le abitudini di vita (fumo, uso di lenti a contatto etc.) e le condizioni lavorative (uso del videoterminale) possono contribuire ad aumentarne l’incidenza. Essendo una patologia multifattoriale, oltre ai fattori di rischio già citati, la predisposizione individuale gioca un ruolo determinante.
Caratteristiche comuni nei soggetti con occhio secco sono una maggiore osmolarità e l’instabilità del film lacrimale (minore durata dell’azione lubrificante delle lacrime per ogni singolo battito di ciglia). Queste si traducono in un aumento dell’infiammazione a livello della superficie oculare che a sua volta va ad aggravare il quadro di disfunzione del film lacrimale, chiudendo un vero e proprio circolo vizioso.
Il sintomo principale dell’occhio secco è la sensazione di corpo estraneo e/o sabbia all’interno dell’occhio; ulteriori sintomi possono includere bruciore, eccessiva lacrimazione (paradossa), dolore e rossore; raramente si ha un calo del visus.
I disturbi possono aumentare nei luoghi con aria secca o condizionata, in alcuni casi può esserci una lacrimazione eccessiva poiché l’alterazione degli strati lipidici e mucosi non garantisce la permanenza delle lacrime sulla superficie.
I segni clinici possono variare dalla semplice presenza di una cheratopatia puntata superficiale fino a forme severe con formazione di ulcere sterili che, se non trattate, possono portare alla perforazione corneale.
La diagnosi del Dry Eye si basa sull’anamnesi, su un esame clinico completo e sui test clinici. I test clinici valuteranno la funzione delle ghiandole lacrimali (test di Schirmer di tipo 1 e 2), l’integrità dell’epitelio della superficie oculare (colorazione con Fluorescina) e la stabilità del film lacrimale (Tempo di rottura del film lacrimale – BUT).
L’obiettivo della terapia è migliorare la quantità e la qualità del film lacrimale così da lubrificare la superficie oculare. La prima misura terapeutica è certamente rappresentata dai sostituti lacrimali (o lacrime artificiali). Anche le misure di igiene visiva, soprattutto nei casi in cui vi siano fattori ambientali predisponenti, possono migliorare la qualità di vita del paziente nelle prime fasi della patologia. Nei casi più severi e nelle forme notturne si può ricorrere all’utilizzo di pomate, unguenti e colliri a base di siero autologo per cercare di migliorare il trofismo corneale e promuovere la riparazione della superficie oculare. In genere a questi presidi si associa la chiusura temporanea o permanente dei puntini lacrimali, al fine di ridurre la quantità di lacrime riassorbita, e, qualora insorgessero ulcere e perforazioni, interventi volti a ridurre l’esposizione corneale quali la tarsorrafia, il ricoprimento congiuntivale e il trapianto di membrana amniotica.
LE MALATTIE DELLA CORNEA
CHERATITI INFETTIVE E NON INFETTIVE
Le cheratiti sono processi infiammatori a carico della cornea, che rappresenta la principale barriera di difesa oculare, che possono guarire senza sequele (forme superficiali) o lasciando aree di cornea non perfettamente trasparenti definite “leucomi corneali” (forme profonde).
In relazione alla loro eziologia le cheratiti vengono divise in “cheratiti infettive” e “cheratiti non infettive”, che possono essere di tipo ulcerativo e non ulcerativo.
Tra le ulcere di tipo infettivo distinguiamo forme batteriche (Pseudomonas e Staphylococcus Aureus, fungine (funghi filamentosi e lieviti come la Candida), virali (tra le più frequenti troviamo l’Herpes Simplex Virus) e protozoarie (Acanthamoeba).
In presenza di un’ulcera non infettiva, invece, bisogna sospettare una patologia autoimmune, infiammatoria o neurotrofica, escludere tossicità causata da farmaci e valutare la presenza di congiuntivite allergica. Altre cause di cheratite sterile possono essere le ustioni chimiche (acidi o alcali), fisiche (raggi ultravioletti) e le malformazioni o infiammazioni palpebrali.
I soggetti più a rischio sono: portatori di lenti a contatto (le lenti possono provocare micro erosioni), pazienti con occhio secco o altre patologie della superficie oculare, pazienti immunosoppressi, recente terapia steroidea prolungata, traumi recenti (soprattutto con materiale vegetale), pazienti affetti da Herpes Zoster (soprattutto in caso di interessamento cutaneo di naso e palpebre), pazienti che non utilizzano protezioni durante esposizione a raggi ultravioletti.
La maggior parte dei pazienti presenta epifora, fotofobia, occhio rosso, crescita dei vasi dal limbus verso il centro della cornea, blefarospasmo, sensazione di corpo estraneo, cefalea e a volte anche vomito.
Se non curate bene le cheratiti possono essere complicate da perdita di tessuto corneale con conseguente formazione di ulcera e rischio di perforazione.
La gravità può essere variabile e la diagnosi eziologica è essenziale, soprattutto in quelle forme che interessano la cornea centrale dove un trattamento adeguato e tempestivo ha lo scopo di prevenire e limitare un deficit visivo permanente.
Esse rappresentano una delle cause di cecità più importanti nel mondo, soprattutto nei paesi in via di sviluppo.
La terapia, diversa a seconda dell’eziologia, ha l’obiettivo di controllare l’infiammazione, l’infezione e di favorire la ricrescita dell’epitelio corneale.
La terapia delle cheratiti batteriche è rappresentata dall’utilizzo di antibiotici per via topica e/o orale ad ampio spettro, in monoterapia o in associazione (monoterapia con fluorochinolonici o associazione di fluorochinolonici e aminoglicosidici); in qualche caso si ricorre a cortisonici topici necessari per ridurre l’infiammazione.
Nelle cheratiti micotiche la terapia prevede l’utilizzo di antimicotici per via topica in associazione ad antimicotici sistemici; gli antivirali, per via topica e sistemica, vengono invece utilizzati come terapia nelle cheratiti virali.
Infine, nelle forme da Acanthamoeba la terapia antibiotica convenzionale non è efficace e si impiegano colliri particolari (PHMB e biguanidi); la terapia va protratta a lungo, anche per 6 -12 mesi.
La riepitelizzazione viene ottenuta tramite l’utilizzo di lubrificanti, lenti a contatto terapeutiche, oppure mediante chiusura palpebrale con bende o chirurgica. Nei casi in cui sono presenti cicatrici e/o irregolarità della superficie anteriore della cornea o in casi gravi con perforazione corneale in atto si può effettuare un immediato approccio chirurgico tettonico (ricoprimento congiuntivale, cheratoplastica lamellare o perforante).
In alcuni casi, quando la terapia antibiotica è inefficace ad esempio, la cheratoplastica è utile per la rimozione del focolaio settico e per l’esecuzione di esami di laboratorio sul tessuto corneale infetto con lo scopo di individuare l’agente patogeno.
LE DISTROFIE CORNEALI
Le distrofie corneali rappresentano un gruppo di patologie ereditarie ad esordio quasi sempre bilaterale e simmetrico caratterizzate da alterazioni intrinseche del tessuto corneale. Si tratta di patologie complesse, clinicamente e geneticamente eterogenee,
che provocano la perdita di trasparenza corneale a causa di anomalie del metabolismo cellulare dei cheratociti con conseguente accumulo di depositi di natura proteica che possono interessare tutti gli strati della cornea, dall’epitelio all’endotelio.
Interessano circa il 0,09% della popolazione con esordio tra i 5 e 40 anni di età.
Le distrofie corneali sono attualmente classificate nella International Classification of Corneal Dystrophies (IC3D) che divide le distrofie non solo in base al livello di evidenza genetica e fenotipica, ma anche in relazione allo strato di tessuto corneale interessato dal processo patologico.
Le attuali acquisizioni genetiche ed i moderni mezzi diagnostici hanno rivoluzionato il mondo delle distrofie corneali.
I sintomi più comuni sono legati alla riduzione del visus, fotofobia, sensazione di corpo estraneo, erosioni e a volte anche dolore. In alcuni casi, invece, i pazienti sono asintomatici e la diagnosi può essere occasionale.
I trattamenti effettuati sono diversi e dipendono dall’acuità visiva del paziente, dalla sede della distrofia, dalla superficie oculare e dal film lacrimale ed infine dalle condizioni generali del paziente: si passa da trattamenti medici come lacrime artificiali, gel, unguenti, autosiero, agenti iperosmotici e lenti a contatto per bendaggi, a trattamenti para-chirurgici mediante laser ad eccimeri ( cheratectomia fototerapica), fino ad arrivare ad un trattamento chirurgico più invasivo caratterizzato dalla cheratoplastica lamellare o perforante.
A seguire sono descritte le distrofie corneali più comuni.
DISTROFIA DELLA MEMBRANA BASALE EPITELIALE
Nota come distrofia di Cogan o distrofia epiteliale microcistica o "Map-Dot Fingerprint" è la distrofia epiteliale più comune. Tale distrofia è causata dallo sviluppo anomalo della membrana basale dell’epitelio, che fisiologicamente ha la funzione di supporto e ancoraggio dell’epitelio soprastante. In tale condizione le cellule epiteliali non aderiscono perfettamente alla membrana determinando erosioni epiteliali recidivanti che, esponendo le terminazioni nervose del plesso sub-epiteliale, provocano dolore puntorio che compare in genere al risveglio; altri sintomi sono l’aumentata sensibilità alla luce e l’eccessiva lacrimazione. Questa distrofia è bilaterale, l’esordio avviene nella seconda e terza decade di vita; spesso non viene diagnosticata finché non induce erosioni superficiali in quanto il visus è generalmente conservato.
E’ caratterizzata dalla presenza di lesioni puntate e microcistiche, linee disposte a spirale che ricordano le impronte digitali ed aree irregolari a “carta geografica”. La terapia della fase acuta è rappresentata da sostituti lacrimali e lente a contatto; in caso di erosioni corneali ricorrenti si possono eseguire trattamenti più invasivi (micro-punture epiteliali, screeping epiteliale con eventuale trattamento con laser ad eccimeri per rimuovere irregolarità di forma) che tuttavia possono non garantire una soluzione definitiva.
DISTROFIA EPITELIALE DI MEESMANN
È una rara anomalia non progressiva del metabolismo epiteliale corneale. I pazienti possono essere asintomatici, spesso si può osservare la presenza di erosioni recidivanti accompagnate da dolore ed offuscamento visivo. È caratterizzata dalla presenza di piccole ed uniformi cisti intraepiteliali che compaiono nell’area centrale della cornea e si estendono verso il limbus, spesso accompagnata da un lieve assottigliamento corneale. La prognosi rimane favorevole ed il trattamento si basa sull’utilizzo di lubrificanti oculari.
DISTROFIA CORNEALE A LATTICE
Distrofia stromale correlata a mutazioni di TGFB1, è provocata dall’accumulo di depositi di amiloide (evidente con colorazione rosso congo), o fibre proteiche anomale, nello stroma corneale anteriore.
La cornea presenta inizialmente opacità biancastre puntiformi e lineari che con il tempo tendono ad aumentare e addensarsi coinvolgendo la zona ottica centrale; è presente un diffuso haze stromale tale da ridurre l’acuità visiva del paziente anche in maniera grave. In qualche caso questo materiale può depositarsi sotto l’epitelio corneale provocando delle erosioni recidivanti che, esponendo i nervi corneali, provocano dolore intenso.
Negli stadi iniziali la terapia è rappresentata da sostituti lacrimali e lenti a contatto, utili nella riduzione del discomfort oculare, mentre nelle fasi avanzate il trattamento è rappresentato dal trapianto di cornea.
La procedura di scelta in questi casi è la cheratoplastica lamellare anteriore profonda (o DALK) che prevede la sostituzione di tutta la cornea ad eccezione dell’endotelio; tale procedimento elimina il rischio di rigetto immunologico endoteliale (la forma più grave di rigetto poiché può provocare lo scompenso del lembo trapiantato) e si riducono alcune complicanze intra- e post-operatorie. Una complicanza di tale patologia è il rischio di recidiva anche nel lembo donatore trapiantato che può richiedere, anche a distanza di anni, la necessità di un nuovo trapianto.
DISTROFIA CORNEALE GRANULARE DI TIPO I E II
Si tratta di due distrofie stromali autosomiche dominanti correlate, come la distrofia a lattice, a mutazioni di TGFB1.
La distrofia di tipo 1, nota come “distrofia granulare di Groenow” è dovuta all’accumulo di depositi ialini amorfi ed è caratterizzata dalla presenza di depositi stromali anteriori centrali bianchi e ben distinti simili a granelli di zucchero o briciole di pane separate da stroma trasparente. Il paziente riferisce bagliore e fotofobia, con offuscamento visivo alla progressione della malattia; rara è la comparsa di erosioni recidivanti.
La distrofia di tipo 2 è una variante mista (granulare-lattice), nota come “distrofia di Avellino”, è dovuta all’accumulo di depositi sia di amiloide sia ialini ed è caratterizzata da fini opacità superficiali che progrediscono a formare lesioni anulari o stellate; a volte
sono associate ad opacità lineari più profonde. Le erosioni recidivanti tendono ad essere lievi e la diminuzione dell’acuità visiva è un evento tardivo.
Il trattamento indicato è la cheratoplastica lamellare anche se, a volte, le opacità stromali superficiali possono essere ablate mediante cheratectomia fototerapica (PTK) senza rimuovere tutta la cornea.
LA DISTROFIA ENDOTELIALE DI FUCHS
È una patologia corneale caratterizzata da un progressivo e lento deterioramento dell’endotelio corneale; più comune nelle donne e generalmente esordisce a partire dalla mezza età. In questa patologia le cellule endoteliali, che normalmente hanno il compito di mantenere la cornea trasparente, vanno incontro a fenomeni di degenerazione che ne compromettono la sua funzione: la cornea si ispessisce e si riempie di acqua (edema), perde la sua trasparenza comportando una marcata e progressiva riduzione della vista; spesso può insorgere dolore acuto a causa della rottura delle bolle epiteliali. L’acuità visiva rimane normale durante le fasi iniziali della patologia; I pazienti affetti riferiscono inizialmente un appannamento della vista peggiore al mattino (con lieve miglioramento nel corso della giornata) poiché la cornea è più spessa al risveglio a causa della mancata evaporazione notturna; negli stadi avanzati la cornea resta opaca tutto il giorno senza miglioramenti.
Nella distrofia di Fuchs si possono distinguere tre fasi in base alla comparsa dei segni patognomonici della patologia corneale:
-
Graduale aumento della “cornea guttata centrale”, che conferisce all’endotelio un aspetto a “metallo battuto”;
-
Scompenso endoteliale con annebbiamento visivo che si riduce durante la giornata;
-
Edema stromale ed epiteliale persistente con formazione di bolle, “cheratopatia bollosa”, con dolore e fastidio se si verifica una rottura delle stesse; può sopraggiungere fibrosi stromale.
La terapia risolutiva è rappresentata dal trapianto di cornea, che attualmente è di tipo lamellare posteriore (DSAEK, UT-DSAEK o DMEK), con la sostituzione del solo strato endoteliale; tale procedura assicura un recupero funzionale molto più rapido rispetto ad una cheratoplastica perforante convenzionale e rischi intraoperatori decisamente ridotti.
MICROSCOPIA ENDOTELIALE
Consiste nella valutazione dello strato corneale più importante e profondo, l’endotelio, che con la sua costante attività mantiene trasparente la cornea.
Mediante apparecchiature dedicate, che richiedono, o meno, il contatto con l’occhio, si possono ottenere fotografie ad elevata risoluzione della superficie più interna della cornea; tali immagini sono successivamente elaborate da un sistema di analisi che ne definisce numerosi parametri, fra cui la densità cellulare, la regolarità di forma e la qualità del mosaico.
Questo esame è eseguito in tutte le patologie che interessano l’endotelio corneale (distrofie e degenerazioni endoteliali), ma soprattutto rientra negli esami preliminari da eseguire prima di chirurgia sul segmento anteriore (cataratta, glaucoma, trapianto di cornea) o in chirurgia refrattiva.
PACHIMETRIA CORNEALE
È un esame che permette di valutare lo spessore della cornea;
tale valore si misura in micron (millesimi di millimetro) e i valori normali sono mediamente compresi tra i 520-540 µm.
L’esame può essere eseguito con diverse tecniche di cui le più utilizzate sono la pachimetria ad ultrasuoni e la pachimetria ottica (vedi tomografia corneale).
Nella pachimetria ad ultrasuoni lo spessore corneale è misurato con una sonda posta a contatto con la superficie corneale dopo instillazione di un collirio anestetico. L’esame risulta rapido ed indolore, ma richiede una discreta collaborazione da parte del paziente al quale viene richiesto di fissare una sorgente luminosa per qualche secondo. Si possono sottoporre alla misurazione anche i bambini purché siano in grado di collaborare.
La pachimetria ottica non prevede l’istillazione di un collirio anestetico, non essendo previsto il contatto con la superficie oculare ed è meglio tollerata della precedente; alcuni pachimetri ottici possono fornire una mappa pachimetrica che consente di analizzare lo spessore corneale nei suoi vari punti.
Questo esame svolge un ruolo importante nella gestione di alcune patologie come il glaucoma, in quanto fornisce il fattore di correzione necessario ad individuare la reale pressione intraoculare, o nella valutazione di alcune patologie corneali come l’edema corneale e il cheratocono che sono caratterizzate da un anomalo spessore corneale.
La pachimetria corneale è importante, inoltre, per coloro che si devono sottoporre a interventi di chirurgia corneale (chirurgia refrattiva, trapianto di cornea, cross-linking).
Nell’ambito della chirurgia refrattiva, ad esempio, permette di stabilire l’entità della correzione ottenibile, poiché pazienti con cornee sottili spesso non possono correggere completamente il loro difetto refrattivo, questo perché l’eccessiva riduzione dello spessore corneale potrebbe causare uno sfiancamento del tessuto stesso.
TOPOGRAFIA CORNEALE
È un esame diagnostico che fornisce informazioni sulla curvatura della superficie corneale anteriore.
Lo strumento utilizzato, definito topografo, analizza i dati derivanti dalla riflessione di anelli luminosi concentrici (disco di Placido) proiettati sulla cornea e li trasforma in mappe colorate (topografiche) che ne descrivono la forma e la regolarità della superficie anteriore.
La topografia è un esame non invasivo, indolore e semplice da eseguire, purché il paziente risulti collaborante. La durata dell’esame è di pochi minuti.
È un esame molto sensibile ed è possibile, attraverso quest’ultimo, evidenziare tutte le alterazioni di riflessione della cornea e riconoscere anomalie anche molto iniziali della curvatura corneale, tra cui il cheratocono.
Ad oggi il suo utilizzo è stato relativamente ridotto grazie all’introduzione della tomografia corneale che è in grado di fornire informazioni aggiuntive, quali lo spessore corneale e la morfologia della faccia posteriore della cornea.
GLAUCOMA
Il glaucoma (o neurotticopatia glaucomatosa) è una patologia oculare neurodegenerativa caratterizzata dal danneggiamento progressivo delle cellule della testa del nervo ottico, anche definita “papilla ottica”, si tratta di una delle cause principali di cecità in tutto il mondo.
Le alterazioni della testa del nervo ottico, che si accompagnano inevitabilmente ad alterazioni del campo visivo, possono rimanere asintomatiche fino agli stadi avanzati della patologia, ciò aumenta la presenza di casi non diagnosticati.
L’incidenza del glaucoma aumenta con l’aumentare dell’età e colpisce il 2-3% dei soggetti di età superiore a 40 anni.
CLASSIFICAZIONE
Esistono varie classificazioni della patologia glaucomatosa basate sull’epoca di insorgenza (congenito o acquisito), sulla eziopatogenesi (primario o secondario) o sulla forma dell’angolo irido-corneale.
Quest’ultima è la classificazione più utilizzata; se l’angolo irido-corneale è aperto si parla di GLAUCOMA AD ANGOLO APERTO, se è chiuso si parla di GLAUCOMA AD ANGOLO CHIUSO.
Il glaucoma cronico ad angolo aperto rappresenta la forma più comune.
La causa del glaucoma primario ad angolo aperto non è ancora nota e i meccanismi patogenetici attraverso i quali si sviluppa un glaucoma sono ancora solo ipotizzati.
I fattori di rischio sono numerosi, il principale è rappresentato da una pressione intraoculare (IOP, Intra Ocular Pressure) elevata, altri sono l’età, l’etnia, l’ereditarietà, la miopia, fattori vascolari, terapia topica prolungata a base di corticosteroidi, etc.
L’aumento della IOP può essere determinato da un ostacolo al deflusso dell’umor acqueo o da un’aumentata produzione di quest’ultimo. L’umore acqueo è prodotto dai corpi ciliari, localizzati dietro l'iride e nutre le strutture anteriori del bulbo oculare, esso viene eliminato a livello del “trabecolato”, in corrispondenza dell'angolo della camera anteriore. Il mancato equilibrio tra la quantità di umor acqueo prodotta e quella eliminata è responsabile dell’aumento della pressione interna dell'occhio (IOP) e della degenerazione delle cellule ganglionari.
SINTOMATOLOGIA
Per quanto riguarda la sintomatologia è importante fare una distinzione tra forma acuta e forma cronica.
Il glaucoma cronico ha, solitamente, una presentazione subdola ed è asintomatico, motivo per cui, se non diagnosticato precocemente, può portare a un’importante compromissione della funzionalità visiva. I sintomi compaiono gradualmente e sono aspecifici. Nel momento in cui il paziente si accorge della presenza di aree cieche (scotomi) del campo visivo, la malattia è già di grado avanzato. Per questo motivo spesso la diagnosi è tardiva; è, infatti, necessaria la perdita di almeno il 50% del patrimonio delle cellule ganglionari perché il deficit del campo visivo periferico sia notato dal paziente.
La compromissione visiva inizia dalla periferia e prosegue verso il centro fino al raggiungimento, nei casi più gravi della cosiddetta “visione tubulare” conseguente al marcato restringimento del campo visivo. Diversa invece è la sintomatologia in caso di un glaucoma acuto, caratterizzato dall’improvviso ed elevato aumento della pressione intraoculare. Nella maggior parte dei casi si presenta con visione annebbiata, intenso dolore oculare e perioculare, mal di testa con tipica irradiazione di tipo trigeminale: a livello oculare, della regione frontale, al cuoio capelluto, al naso, alle labbra, alla mascella e alla mandibola; possono inoltre essere presenti segni e sintomi sistemici quali nausea e vomito.
DIAGNOSI
La diagnosi di glaucoma è effettuata attraverso quattro esami fondamentali:
ESAME FONDO OCULARE: permette di valutare la papilla ottica e in particolare il rapporto tra la sua ampiezza e la sua escavazione (il cosiddetto rapporto CUP/DISC).
ESAME DEL CAMPO VISIVO: è l’esame indispensabile per effettuare diagnosi di glaucoma ed è molto utile nella fase di follow-up, per valutare la progressione del danno e l’efficacia terapeutica; l’esame del campo visivo computerizzato (o perimetria computerizzata) permette di determinare l’entità e la progressione del danno delle fibre nervose ganglionari.
TONOMETRIA OCULARE: è la tecnica che consente la misurazione della pressione interna dell'occhio; il valore di questo parametro è espresso in millimetri di mercurio (mmHg). I valori fisiologici sono generalmente compresi tra 9 e 20 millimetri di mercurio, la gamma dei valori è relativamente ampia e deve sempre essere considerata l'individualità del caso.
Esistono varie metodiche per la misurazione della pressione intraoculare (IOP) che differiscono per principio di funzionamento, riproducibilità e semplicità d’esecuzione (indentazione di Schioetz, Tonopen, a soffio, a rimbalzo, etc.) ma l’esame più affidabile e, quindi, di riferimento è la Tonometria ad applanazione di Goldmann.
Questo strumento misura la forza meccanica che è necessario imprimere per appiattire temporaneamente la parte centrale della cornea.
L’esame è rapido e indolore, richiede l’applicazione di un anestetico topico, per evitare qualsiasi fastidio durante la misurazione, e l’ausilio di fluoresceina, un colorante che viene applicato a livello congiuntivale. La tonometria ad applanazione richiede l'uso della lampada a fessura, il paziente dovrà collaborare cercando di rimanere fisso con lo sguardo e limitando il più possibile la chiusura delle palpebre per pochi secondi al fine di evitare errori nella misurazione.
Dal momento che la pressione intra-oculare varia durante il giorno sarebbe utile ripetere la misurazione per entrambi gli occhi in almeno 2-3 occasioni per migliorare la valutazione del tono oculare; in alcuni casi, è più opportuno eseguire una curva tonometrica, ossia una serie di misurazioni lungo l'arco della giornata.
I valori così ottenuti non devono mai essere considerati in modo assoluto, ma vanno sempre rapportati ai risultati della pachimetria corneale (che misura lo spessore corneale).
La misurazione della pressione oculare è importante perché un aumento di questo parametro rappresenta il fattore di rischio principale per lo sviluppo del glaucoma, una patologia che, se trascurata, può portare a perdita o riduzione importante definitiva della vista; la tonometria è un esame fondamentale sia per la diagnosi che per il monitoraggio dell'efficacia della terapia in questa patologia.
GONIOSCOPIA: è un esame diagnostico essenziale per la classificazione del glaucoma e, di conseguenza, per la scelta della terapia più idonea. L’esame viene eseguito attraverso l’utilizzo di una particolare lente posta a contatto con l’occhio del paziente, grazie alla quale è possibile osservare l’angolo irido-corneale, permettendo di valutare il grado di apertura dell’angolo, la presenza di eventuali anomalie congenite (per esempio residui embrionali) o acquisite (sinechie, neovasi, pigmento, etc.). Si tratta di una procedura sicura e indolore, l’esame viene effettuato alla lampada a fessura dopo l’instillazione di una goccia di collirio anestetico.
Al fine di aumentare la sensibilità della diagnosi sono state recentemente proposte ulteriori indagini strumentali che utilizzano specifici sistemi di “imaging” della papilla ottica con l’obiettivo di riconoscere forme sub-cliniche di glaucoma e semplificare il follow-up dei pazienti in terapia; una di queste tecniche è rappresentata dalla tomografia a coerenza ottica (OCT) che fornisce informazioni prevalentemente sulla morfologia e funzionalità delle fibre nervose.
Per prevenire i danni al nervo ottico è fondamentale effettuare una diagnosi precoce, questo è possibile mediante visite oculistiche di controllo periodiche in cui viene ripetuto l’esame del fondo oculare e il monitoraggio della IOP, ma soprattutto attraverso il monitoraggio dell’esame del campo visivo.
TERAPIA
Nel glaucoma cronico la terapia si basa sulla riduzione della pressione intraoculare che rappresenta, ancora oggi, l’unico fattore di rischio modificabile. A tal proposito si può intervenire farmacologicamente e/o chirurgicamente.
Ai farmaci in grado di normalizzare la IOP (farmaci con attività ipotonizzante) sono spesso associati farmaci con attività neurotrofica e neuro-protettrice specifica per il nervo ottico.
Nei casi in cui la terapia farmacologica si riveli insufficiente a controllare la pressione intraoculare o la progressione del danno anatomo-funzionale è necessario ricorrere a terapie parachirurgiche (laser) o chirurgiche.
La Laser Trabeculoplastica Selettiva è una variante della classica trabeculoplastica argon laser, indicata nei casi di glaucoma ad angolo aperto, consiste nell' esecuzione di stimolazioni termiche a livello del trabecolato tali da determinare un incremento della sua capacità di deflusso dell’umor acqueo con conseguente calo della pressione intraoculare.
L’iridotomia YAG laser è indicata, oltre che in caso di glaucoma acuto e di glaucoma ad angolo stretto/chiuso, anche a scopo profilattico in tutti gli occhi con tale predisposizione anatomica che con il passare degli anni rischiano l’insorgenza di tali patologie.
I trattamenti laser sono procedure ambulatoriali che vengono effettuate in anestesia topica, attraverso la somministrazione di un collirio anestetico, sono, quindi, indolori.
La terapia chirurgica del glaucoma, come la terapia medica e la terapia laser, è rivolta ad eliminare l’ipertensione oculare, nel corso degli anni sono stati proposti numerosi interventi chirurgici del glaucoma gran parte dei quali con lo scopo di realizzare nuove vie di deflusso dell’umor acqueo; molti interventi hanno lo scopo di deviare l’umor acqueo verso lo spazio sotto-congiuntivale (chirurgia filtrante).
Tra le procedure chirurgiche la trabeculectomia rappresenta l’intervento più eseguito, si tratta di un intervento filtrante, protetto che prevede l’asportazione di una piccola porzione profonda di tessuto oculare esterno (limbus corneo-sclerale contenente il trabecolato e il canale di Schlemm) creando una sorta di “sportellino” da cui far defluire l’umor acqueo, facendo così diminuire la pressione interna dell’occhio.
Tra le procedure di chirurgia filtrante rientra il posizionamento di valvole che drenano l’umore acqueo nello spazio sottocongiuntivale, le più impiegate sono la valvola di Baerveldt e quella di Ahmed.
Le tecniche più innovative si basano sulla chirurgia mini-invasiva (MIGS: Minimally Invasive Glaucoma Surgeries), tra queste ricordiamo lo XEN, si tratta di un piccolo tubicino di drenaggio morbido che viene posizionato nell’occhio a livello dell’angolo irido-corneale permettendo il drenaggio dell’umor-acqueo nello spazio sub-congiuntivale e di conseguenza la riduzione della pressione intra-oculare.
CAMPO VISIVO
L’esame computerizzato del campo visivo è un esame diagnostico che fornisce un’analisi dello spazio visivo percepito dai nostri occhi mediante l’ausilio di un dispositivo chiamato Perimetro o Campimetro; nello specifico, esso consente lo studio della sensibilità luminosa retinica e dell’integrità delle vie ottiche ed è in grado di evidenziare la presenza di un danno funzionale anche di lieve entità.
È un esame non invasivo e non doloroso, di durata variabile dai 10 ai 20 minuti; viene di norma eseguito al buio, valutando un occhio per volta.
L’esame consiste nella presentazione intermittente di stimoli luminosi, d’intensità differente, proiettati all’interno della cupola presente nel Perimetro, secondo un ordine casuale.
Il paziente, una volta sistemato con mento e fronte sullo specifico supporto del Perimetro, viene fornito di un pulsante da azionare ogni qualvolta vedrà apparire gli stimoli luminosi sopracitati.
I risultati ottenuti sono elaborati e rappresentati sotto forma di valori numerici, d’indici e di mappa in scala di grigi o colore. È indispensabile una collaborazione attenta da parte del paziente al fine di ottenere un esame attendibile.
Lo studio del campo visivo è indicato, principalmente, per le patologie oculari e/o neurologiche che causano un danno a carico delle vie ottiche (es. adenoma ipofisario, ictus cerebrali, neuropatie ottiche retro-bulbari, neuropatie ottiche ischemiche, ecc.).
Di queste patologie, il glaucoma rappresenta l’indicazione più frequente nella pratica clinica.
La perimetria computerizzata, infatti, è l’esame diagnostico di riferimento per la diagnosi e il monitoraggio della patologia glaucomatosa poiché capace di individuare e caratterizzare anche quelle alterazioni iniziali che il paziente stesso non riesce a percepire.
In particolare, i primi difetti del campo visivo in un paziente glaucomatoso sono rappresentati dalla comparsa di punti di depressione della sensibilità nell'area paracentrale e/o dalla presenza di un’asimmetria della sensibilità fra gli emi-campi nasali, superiore ed inferiore (cosiddetto “salto nasale”), e/o dall'allargamento della macchia cieca (meno specifico).
Nelle fasi intermedio-avanzate del glaucoma, i difetti diventano sempre più marcati ed estesi sino a restringere notevolmente il campo visivo con residua visione tubulare (scotoma anulare). Lo stadio terminale del glaucoma, purtroppo, è rappresentato dalla cecità sensoriale.
CORIORETINOPATIA SIEROSA CENTRALE

La Corioretinopatia Sierosa Centrale (CRSC) è una malattia retinica caratterizzata da una raccolta di fluido al di sotto della porzione centrale della retina (macula). Il fluido proviene dai vasi della coroide (strato vascolare che si trova al di sotto della retina e da cui i fotorecettori traggono nutrimento) e attraverso aumento della permeabilità dell’epitelio pigmentato retinico passa al di sotto della retina.
La CRSC è una malattia che predilige maschi di età compresa tra i 30 e i 50 anni. Le donne sono colpite in età più avanzata. Spesso colpisce persone con una personalità di tipo A, ossia particolarmente attive, con atteggiamento competitivo, facilmente suscettibili allo stress. Le condizioni che determinano un aumento del cortisolo nel sangue come l’assunzione di terapia con corticosteroidi, la sindrome di Cushing, la gravidanza, rappresentano un altro fattore di rischio.
Sintomi
L’esordio dei sintomi è in genere subdolo e monolaterale. Il paziente percepisce una visione offuscata, distorsioni delle immagini (metamorfopsie), scotoma centrale, può percepire i colori come più sbiaditi (discromatopsia). L’acuità visiva si mantiene in genere intorno ai 3/10 – 6/10 e può migliorare con l’uso di lenti positive poiché l’accumulo di fluido sposta in avanti la retina causando la convergenza dei raggi luminosi dopo di essa. L’occhio controlaterale può essere asintomatico, ma spesso si riscontrano alterazioni extra-foveali che quindi non compromettendo la zona centrale della retina, non vengono percepite dal paziente.
La CRSC acuta, al primo episodio, si risolve spontaneamente nel 80% dei casi, ma tende a recidivare nel 45-50% e può diventare cronica per la presenza di aree di scompenso persistente dell’epitelio pigmentato retinico. La persistenza del fluido sottoretinico, soprattutto in pazienti con recidive multiple, può determinare sofferenza e danno ai fotorecettori con compromissione visiva anche grave.
Diagnosi
Il paziente deve essere sottoposto a esame del fondo oculare che evidenzia il tipico sollevamento sieroso della retina nella regione maculare che può essere associato a distacchi sierosi dell’epitelio pigmentato retinico. Nelle forme croniche si possono riscontrare zone di atrofia dell’epitelio pigmentato, degenerazione maculare cistoide, fibrosi sottoretinica e neovascolarizzazione coroideale.
Per la diagnosi sono utilizzati anche esami strumentali come la fluorangiografia retinica (FAG), l’angiografia con il verde di indocianina (ICG) e la tomografia a coerenza ottica (OCT).
La FAG è un esame invasivo che si avvale della somministrazione di un colorante per via endovenosa, la fluoresceina, e serve per studiare la vascolarizzazione della retina. Nella CRSC si riscontra una dispersione di colorante focale o multifocale a livello dell’epitelio pigmentato retinico con aspetti tipici come a “macchia di inchiostro” o a “ciminiera”. Si possono evidenziare anche distacchi dell’epitelio pigmentato che risultano iperfluorescenti. Nelle forme croniche la FAG mette in evidenza aree di scompenso dell’epitelio pigmentato (epiteliopatia retinica).
L’ICG è un esame simile alla FAG, cambia il tipo di colorante somministrato (verde di indocianina). Questo esame mette in evidenza i vasi della coroide. Nella CRSC si riscontrano aree di iperpermeabilità coroideale in corrispondenza di alterazione dell’epitelio pigmentano evidenziate dalla FAG, ma anche in zone dove l’epitelio pigmentato appare integro. Questo esame permette inoltre di evidenziare la presenza di neovascolarizzazioni coroideali o polipoidi, condizioni che possono simulare una CRSC o complicarne la forma cronica.
L’OCT è un esame non invasivo che permette di valutare gli strati della regione centrale della retina. Nella CRSC viene utilizzato per valutare e monitorare in modo obiettivo e misurabile il sollevamento retinico maculare, particolarmente utile nel follow-up. L’OCT permette anche di evidenziare piccoli distacchi del neuroepitelio e dell’epitelio pigmentato difficilmente valutabili all’esame del fondo oculare. Nelle forme croniche si possono evidenziare cavità cistoidi intraretiniche e distacchi piani irregolari dell’epitelio pigmentato che possono nascondere neovascolarizzazioni. Le neovascolarizzazioni possono essere messe in evidenzia dalla tomografia a coerenza ottica-angiografia (OCTA), un esame simile all’OCT, non invasivo, che permette di valutare gli strati vascolari della retina e della coriocapillare.
Trattamento
Considerando che nella maggior parte dei casi la CRSC acuta si risolve spontaneamente, il trattamento dovrebbe essere riservato ai casi in cui il distacco maculare persiste per più di 2-3 mesi, vi sia un progressivo peggioramento visivo, episodi ricorrenti, essudazioni gravi ed estese.
La terapia della CRSC si avvale di laser retinici come la fotocoagulazione retinica diretta sul punto di perdita del fluido da parte dell’epitelio pigmentato retinico che si evidenzia con la FAG. Questo punto deve essere distante almeno 300 µm dal centro maculare. La fotocoagulazione laser viene utilizzata in particolare per le forme acute, perché in quelle croniche le zone da cui proviene il fluido sono mal definite.
La CRSC cronica o con punto di fuga prossima al centro della macula possono essere trattate tramite terapia fotodinamica in cui viene iniettata in vena del paziente una sostanza fotosensibilizzante, la verteporfina, poi stimolata con un particolare laser a livello della zona retinica che si vuole trattare. Tale area viene stabilita in base alle zone che mostrano alterata permeabilità coroideale all’ICG. I dosaggi utilizzati attualmente sono più bassi rispetto a quelli precedentemente usati per il trattamento delle neovascolarizzazioni coroideali.
Attualmente viene sempre più utilizzato, in particolar per le forme acute, il laser micropulsato sottosoglia, un particolare laser che non provoca danno a livello retinico ma esercita un’azione di riscaldamento che stimola la produzione da parte dell’epitelio pigmentato retinico di sostanze antinfiammatorie e antiedemigene.
Nel caso in cui si sviluppi una neovascolarizzazione coroideale come complicanza al trattamento fotodinamico può essere associata l’iniezione intravitreale di anti-VEGF.
Sono state tentate numerose terapie farmacologiche per la CRSC, come ad esempio eplerenone, acetazolamide, betabloccanti, finasteride, rifampicina, ketokonazolo, ma nessuna di queste terapie sembra per ora efficace.
DEGENERAZIONE MACULARE SENILE
La degenerazione maculare legata all’età (DMLE) è una malattia che colpisce la parte centrale della retina, la macula. La DMLE è la causa più comune di grave e irreversibile riduzione visiva nel mondo occidentale nelle persone di età maggiore di 60 anni.
La DMLE colpisce le cellule della macula, le più sensibili del sistema visivo, provocandone la degenerazione e la morte e la progressiva sostituzione da tessuto cicatriziale con conseguente compromissione della visione centrale.
Classificazione
La DMLE viene classificata in: iniziale (o secca) ed evoluta (forma essudativa o neovascolare, e atrofica).
La DMLE inziale o secca è caratterizzata da accumuli di materiale di scarto derivante dal metabolismo insufficiente o alterato dell’epitelio pigmentato retinico, chiamati drusen. In questo stadio il paziente mantiene in genere una buona acuità visiva.
La DMLE essudativa o neovascolare provoca una grave perdita della capacità visiva a causa della formazione di neovasi al centro della macula. Questi vasi nella maggior parte dei casi derivano dallo strato sottostante alla retina, la coroide. Sono la causa di accumulo di liquido a livello maculare e con la progressione della malattia provocano la formazione di una cicatrice fibrovascolare e distruzione della retina maculare.
La DMLE atrofica si caratterizza, in genere, per una lenta e progressiva morte delle cellule retiniche fino alla formazione di alterazioni atrofiche della retina e della coriocapillare in sede maculare.
Fattori di rischio
Il fattore di rischio principale è indubbiamente l’invecchiamento, altri fattori di rischio riconosciuti sono: il fumo di sigaretta, la familiarità, l’ipertensione arteriosa, consumo di alcol ed esposizione alla luce solare.
Sintomi
Nelle fasi iniziali la DMLE è in genere asintomatica, uno dei primi sintomi è la presenza di metamorfopsie, ossia percezione di immagini distorte, con difficoltà nella lettura e sovrapposizione dei caratteri di stampa; riduzione dell’acuità visiva. Nella forma atrofica la comparsa dei sintomi è graduale e progressiva, mentre nella forma essudativa i sintomi possono comparire in modo repentino con la caratteristica comparsa di una macchia scura al centro del campo visivo (scotoma centrale).
La DMLE non provoca la cecità completa in quanto la visione periferica è conservata.
Diagnosi
La diagnosi di DMLE deve prima di tutto tenere conto dei sintomi soggettivi riferiti dal paziente, l’esame del fondo oculare e l’utilizzo di tecniche di imaging come la fluorangiografia retinica (FAG), l’angiografia con il verde di indocianina (ICG), la tomografia a coerenza ottica (OCT) e la tomografia a coerenza ottica-angiografia (OCTA). Questi esami permettono di formulare una corretta diagnosi per impostare la miglior strategia terapeutica per il paziente, oltre a valutare l’andamento della patologia nel tempo.
Utile per la valutazione delle metamorfopsie è un esame chiamato Test di Amsler (, si tratta di un quadrilatero quadrettato che deve essere posto a distanza di 30 cm e osservato con la migliore correzione per la lettura da vicino. Dopo aver coperto un occhio, con quello scoperto il paziente deve fissare un punto nero che si trova al centro del reticolo. Quando vi è una maculopatia le linee possono apparire ondulate, deformate o discontinue. Al paziente con DMLE iniziale viene assegnato questo test anche a casa in modo che possa accorgersi in modo tempestivo di cambiamenti e quindi contattare il proprio oculista.
Terapia
Prevenzione: studi clinici, in particolare lo studio AREDS (Age-Related Eye Disease Study) hanno evidenziato l’efficacia nell’utilizzo di alte dosi vitamina C, vitamina E, beta-carotene e zinco nel ridurre il rischio di progressione verso la forma avanzata in pazienti con DMLE iniziale.
Terapia antiangiogenica: la forma essudativa viene trattata con iniezioni intravitreali di farmaci che agiscono inibendo il fattore di crescita dell’endotelio vascolare (anti VEGF), fattore che risulta essere alla base dello sviluppo dei neovasi.
Attualmente i farmaci approvati dall’Agenzia Italiana del Farmaco sono il Ranibizumab (Lucentis®) e Aflibercept (Eylea®), un altro farmaco utilizzato ma in modalità off-label (ossia non approvata dall’AIFA per il trattamento delle maculopatie) è il Bevacizumab (Avastin®). Questi farmaci vengono somministrati inizialmente con cadenza mensile, successivamente possono essere attuate diverse strategia terapeutiche anche in base alla risposta del paziente.
Terapia fotodinamica: è tra le prime terapie nate per il trattamento della DMLE di tipo essudativo. Consiste nella somministrazione di un farmaco che si attiva con l’azione di una particolare luce (farmaco fotosensibilizzante) la verteporfina. Questo farmaco viene somministrato per via endovenosa e successivamente l’area retinica interessata dalla neovascolarizzazione viene stimolata con un laser particolare. Questo provoca la liberazione di radicali liberi dell’ossigeno con successivo danno cellulare e occlusione selettiva dei vasi a livello del tessuto bersaglio. La terapia fotodinamica viene utilizzata per alcune forme particolari di neovascolarizzazione, in particolare quelle chiamate “polipoidali” da sola o in combinazione con i farmaci anti-VEGF.
Terapia laser fotocoagulante: è utilizzata per il trattamento di alcune forme di DMLE in cui le neovascolarizzazioni non sono localizzate nella zona centrale (neovascolarizzazioni extrafoveali).
Riabilitazione visiva: i pazienti affetti da DMLE possono trarre beneficio dalla riabilitazione visiva. Si tratta di un percorso che aiuta il paziente a imparare a sfruttare al massimo le capacità visive funzionali residue nella visione da vicino. Ai pazienti viene insegnato a leggere in ambienti ben illuminati, a spostare molto la fissazione per poter cogliere maggiori dettagli e ad utilizzare lenti di ingrandimento o potenziare le lenti per vicino per aumentare il loro effetto di ingrandimento. Esistono anche ausili visivi che permettono di ingrandire le immagini da 2x e 16x, oppure video-ingranditori.
Novità: recentemente la Commissione Europea ha approvato un nuovo anti-VEGF, il brolucizumab (Beovu®). Il vantaggio di questo nuovo farmaco rispetto ai precedenti è la sua durata di azione maggiore che offre la possibilità di effettuare la terapia con un intervallo di dosaggio di tre mesi. Un altro nuovo anti-VEGF attualmente in valutazione della FDA e della EMA è Abicipar, anche questo farmaco si propone come un anti-VEGF a lunga durata d’azione.
Ad oggi le terapie disponibili sono incentrare sul trattamento della forma essudativa, ma numerosi studi stanno valutando l’efficacia di farmaci per il trattamento della forma atrofica.
DISTACCO DI RETINA
Il distacco di retina (DR) consiste nella separazione della retina neurosensoriale (la porzione più interna, deputata alla funzione visiva) dall’epitelio pigmentato retinico (la porzione più esterna, deputata a funzioni trofiche e di supporto). Nel momento in cui vi è una separazione tra le due componenti retiniche vi è un’interruzione nell’apporto nutritivo nei confronti della retina neurosensoriale per cui si assiste ad una perdita improvvisa della funzionalità visiva. Se la retina neurosensoriale resta distaccata per molto tempo (i primi danni irreparabili si realizzano già a partire da 48 ore dopo l’insorgenza del distacco) si assiste ad un processo di apoptosi (cioè di morte cellulare) per cui il recupero visivo risulta estremamente limitato.
Il DR può essere di 3 tipi: regmatogeno, dovuto ad una rottura retinica che permette al vitreo (la sostanza gelatinosa che occupa la cavità interna dell’occhio) di passare posteriormente permettendo così lo scollamento della porzione aderente della retina (parzialmente nelle fasi iniziali fino ad un distacco totale in assenza di trattamento chirurgico); trazionale, generato da briglie di tessuto fibro-vascolare (formate all’interno della cavità vitreale, che esercitano una trazione centrifuga sulla retina cosicchè da scollarla); essudativo (solitamente dovuto ad essudazione di liquido che si posiziona sotto la retina scollandola).
Nelle fasi iniziali di un DR (soprattutto se di tipo regmatogeno) ci possono essere in certi casi dei sintomi premonitori come visione di flash luminosi (fosfeni), di corpi mobili (le cosiddette mosche volanti o miodesopsie), frequenti anche fisiologicamente in caso di distacco posteriore di vitreo) fino ad una visione di "tenda scura calata" in caso distacco conclamato (il paziente avverte una visione annebbiata nel settore opposto rispetto alla sede del distacco, per cui se il distacco è nella zona superiore della retina il paziente vedrà annebbiato guardando in basso e viceversa). Nel caso in cui sia coinvolta la zona centrale, il calo del visus è più rapido e marcato (distacco con macula off) e il recupero visivo dopo chirurgia può essere inferiore rispetto a casi con fovea risparmiata (macula on). In caso di DR trazionale alla base della zona interessata sono presenti membrane fibrovascolari che esercitano una trazione tra il vitreo e la retina fino a scollare quest’ultima. La causa più comune in questo caso è la presenza di neovasi in corso di retinopatia diabetica proliferante.
TERAPIA
La terapia è preventiva nel caso in cui siano presenti rotture o aree di assottigliamento del tessuto retinico; in tali circostanze, infatti, un trattamento laser può prevenire l’insorgenza di un successivo DR.
La terapia del DR, una volta che questo sia conclamato, è sempre chirurgica; in certi casi è utile eseguire un trattamento coadiuvante di rinforzo delle zone interessate in fase intra o post-operatoria. Attualmente esistono diverse tecniche chirurgiche per il DR, a seconda dei casi, delle indicazioni e delle scelte da parte del chirurgo: tra queste le più utilizzate sono la tecnica “ab externo” (cerchiaggio e/o piombaggio sclerale associata o meno a criotrattamento e retinopessia con gas, indicato soprattutto in casi di DR regmatogeno) e la tecnica “ab interno” (vitrectomia via pars plana, indicata soprattutto in caso di DR trazionale). In quest’ultima tecnica è spesso impiegato il tamponamento con olio di silicone che funziona con un principio analogo al gas intravitreale; tuttavia, esso non è riassorbile e deve essere rimosso con un ulteriore intervento chirurgico.
DISTACCO POSTERIORE
DI VITREO
Il vitreo, o corpo vitreo è una gelatina trasparente che occupa la porzione d'occhio compresa tra il cristallino e la retina, di cui ne garantisce supporto metabolico e meccanico. Esso è composto per il 99% da acqua e per la restante parte da varie molecole e cellule che ne costituiscono la base. Le fibre di collagene, l'acido ialuronico, diverse cellule connettivali e altre sostanze chimiche (zuccheri e proteine) sono i principali rappresentanti della struttura vitreale.
Sebbene trasparente, il vitreo presenta comunemente alterazioni fisiologiche collegate all'età ed impurità che i pazienti notano e riferiscono come “corpi mobili”. Tali fenomeni aumentano con l’età e con la comparsa di processi di degenerazione vitreale noti con il termine di “sinchisi” e “sineresi” vitreale; questi processi si riferiscono alla fluidificazione ed alla formazione delle lacune che incrementano la visione di ombre o delle cosiddette "mosche volanti" che vengono identificate con il termine “miodesopsie”.
Questi fenomeni di degenerazione contribuiscono a ridurre il volume del corpo vitreo e a stimolare la contrazione delle fibre collagene che portano alla perdita delle sue normali aderenze con la retina, scollando le sue parti posteriori. Tale processo è noto come “distacco posteriore di vitreo” e rappresenta una condizione talmente diffusa (presente nel 50-70% oltre i 65 anni e nelle miopie elevate) da essere considerata quasi “fisiologica”. In molti casi il paziente si accorge dell’avvenuto distacco per la comparsa improvvisa di alterazioni della vista (tremolii o annebbiamento) e per la presenza, nel campo visivo, di un corpo mobile di dimensioni più o meno ampie. Essendo un fenomeno comune è nella maggior parte dei casi, privo di conseguenze; tuttavia, in qualche circostanza, le trazioni vitreo-retiniche che hanno indotto il distacco possono esercitare trazioni analoghe nella periferia retinica o in aree più deboli provocandone la rottura. Per tali ragioni, le miodesopsie possono associarsi alla percezione di fosfeni (lampi di luce, anche al buio ad occhi chiusi), che sono il sintomo di una trazione retinica in atto. Il distacco di vitreo può complicarsi con emorragie e rotture della retina (nel 10-15% dei casi) potenzialmente in grado di provocare il distacco della retina.
Per tale motivo tutti i pazienti che notano la comparsa improvvisa di corpi mobili e soprattutto di fosfeni dovrebbe sottoporsi ad esame del fundus oculare per escludere la presenza di rotture retiniche e complicanze.
Non esiste una terapia medica causale per il trattamento dei corpi mobili e del distacco posteriore del vitreo, né tantomeno una profilassi; infatti, la terapia idrica o a base di integratori e anti-ossidanti non ha mai dimostrato una efficacia significativa nel ripristino della fisiologica composizione del gel. In molti casi i pazienti riferiscono un miglioramento della sintomatologia a distanza di qualche mese dalla comparsa, dovuto a fenomeni di adattamento da parte del cervello e alla possibilità che l’addensamento vitreale si sia spostato liberando l’asse visivo.
FORO MACULARE
Il foro maculare è una soluzione di continuo a livello dell’area centrale della retina, la fovea; a causa delle sue peculiarità anatomiche, tale zona è predisposta a questo tipo di patologia in cui il tessuto neuroretinico va lentamente incontro a un progressivo processo di atrofia. Nella maggior parte dei casi il foro maculare è idiopatico (per cui non è possibile riconoscere un’etiologia definita), anche se esistono numerose condizioni fisiopatologiche che favoriscono la sua insorgenza, come alcune vasculopatie sistemiche, la miopia elevata, l'edema maculare cistoide, la trazione vitreo-maculare, la sindrome dell’interfaccia vitreo-maculare e le membrane epiretiniche, etc. La sua incidenza è prevalente nell’età senile, anche se si possono avere casi in età più giovane.
Dal punto di vista fisiopatologico si ritiene che la contrazione tangenziale, causata dal raggrinzamento del vitreo adeso alla fovea, promuova la separazione della retina sensoriale dal sottostante epitelio pigmentato retinico; la sofferenza del trofismo neuroretinico che ne consegue conduce all'atrofia progressiva della retina foveale. L’evoluzione di tale patologia è graduale, passando attraverso una serie di stadi evolutivi (da 1 a 4, secondo la classificazione attualmente in uso elaborate da Gass) in cui si passa dallo stadio I, “foro maculare incipiente”, allo stadio IV di “foro maculare a spessore completo” con totale separazione del vitreo posteriore; non necessariamente si ha un evoluzione del quadro clinico fino all’ultimo stadio, come anche dimostrato dalla regressione spontanea dei fori incipienti in circa la metà dei casi.
SINTOMATOLOGIA
L’insorgenza del foro maculare, nelle prime fasi, è solitamente asintomatica; infatti, negli stadi iniziali l’interruzione della neuroretina può essere limitata agli strati più interni, configurando il cosiddetto “foro a parziale spessore o “lamellare”. Nelle fasi avanzate, invece, la neuroretina è coinvolta dal processo degenerativo per tutto il suo spessore e compaiono sintomi quali annebbiamento visivo (a volte un calo visivo improvviso), distorsioni delle immagini (metamorfopsie) e zone scure o grigie del campo visivo (scotomi).
DIAGNOSI
L’esame del fondo oculare spesso è sufficiente per porre diagnosi di foro maculare, anche se la tomografia a coerenza ottica (OCT) resta l’esame “gold standard” per la diagnosi ed il follow-up; l'autofluorescenza e la fluorangiografia sono esami di seconda istanza utili per confermare la diagnosi.
TERAPIA
Diverse sono le opzioni terapeutiche, a seconda dello stadio, della sintomatologia, dell’acuità visiva e della prognosi.
Nella maggior parte dei casi i pazienti sono controllati attraverso visite periodiche e non sono attuate ulteriori terapie. La soluzione chirurgica è invece indicata in caso di progressione dello stadio del foro e riduzione dell’acuità visiva del paziente. La chirurgia è rappresentata dalla vitrectomia via pars plana con distacco completo delle aderenze vitreali posteriori, peeling della membrana limitante interna, associate o meno al tamponamento con gas in camera vitrea.
OCCLUSIONI ARTERIOSE RETINICHE

RETINA CRAO
L’occlusione arteriosa retinica si verifica a causa dell’interruzione da parte di un embolo del flusso sanguigno derivante dalla arteria centrale retinica (occlusione arteriosa centrale, CRAO) o uno dei sui rami (occlusione arteriosa di branca retinica, BRAO). È una situazione rara, ma che comporta grave compromissione della funzionalità visiva in quanto l’occlusione, ostacolando l’afflusso di sangue, non permette l’apporto di nutrimenti ai tessuti con conseguente ischemia e morte per infarto della porzione di retina a valle dell’occlusione.
Le occlusioni arteriose retiniche colpiscono maggiormente gli uomini, con età media di insorgenza intorno ai 60 anni, e condividono gli stessi fattori di rischio di infarto cardiaco e ictus cerebrale: ipertensione arteriosa, aumento del colesterolo e dei trigliceridi, diabete mellito, aterosclerosi con stenosi carotidea, arteriti, aritmie, valvulopatie cardiache e difetti della coagulazione del sangue.
Occlusione arteriosa centrale retinica
La CRAO è il tipo di occlusione più frequente. L’arteria centrale retinica viene occlusa da un embolo a livello della sua emergenza dal nervo ottico, questo comporta la compromissione del passaggio di sangue in tutte le sue diramazioni. In circa il 20% della popolazione è presenta una arteria che deriva dalla circolazione coroideale, l’arteria cilioretinica, quando essa è presente il sangue continua a fluire nel suo territorio e, se irrora la macula, la visione centrale può essere risparmiata.
Sintomi
La CRAO si presenta con una perdita della vista monolaterale improvvisa e profonda, senza dolore (tranne nei casi in cui essa sia dovuta ad arterite a cellule giganti che si associa a cefalea, dolore a livello del cuoio capelluto, dolore alla masticazione). La pupilla dell’occhio colpito non reagisce all’illuminazione diretta, mentre si contrae se stimolato l’altro occhio (difetto pupillare afferente relativo, RAPD).
Diagnosi
La diagnosi viene posta tramite osservazione del fondo oculare. La retina appare di colorito biancastro che risalta una macchia rosso-ciliegia in corrispondenza della parte centrale della retina. L’albero vascolare occluso risulta attenuato e nel 20% dei casi è possibile osservare l’embolo nel suo interno, la papilla ottica appare edematosa.
La fluorangiografia retinica (FAG) mette in evidenza il difetto di perfusione delle arterie con aumento del tempo che intercorre tra la somministrazione del colorante in vene e l’arrivo alla retina.
Occlusione arteriosa di branca retinica
La BRAO si instaura quando l’embolo si blocca a livello di una diramazione della arteria centrale retinica, il quadro ha caratteristiche variabili in rapporto all’estensione e alla localizzazione dell’area retinica nutrita dal vaso occluso.
Sintomi
La BRAO comporta una perdita indolore e improvvisa di parte del campo visivo di grado variabile in relazione all’estensione dell’area retinica coinvolta.
L’acuità visiva dipende dal coinvolgimento della regione maculare, se viene occlusa la branca arteriosa che la nutre risulterà fortemente compromessa, mentre se non viene coinvolta la visione centrale sarà conservata.
Diagnosi
All’esame del fondo oculare si osserva edema retinico localizzato nel territorio della branca occlusa, è possibile osservare l’embolo, soprattutto a livello delle biforcazioni delle arterie. La FAG permette di confermare e localizzare con precisione l’area interessata dall’ischemia. L’esame del campo visivo viene utilizzato per valutare l’entità del difetto.
Prognosi e complicanze
In circa il 2% degli occhi affetti da CRAO si possono sviluppare vasi anomali che possono portare a glaucoma neovascolare con aumento elevato della pressione oculare. La prognosi risulta peggiore nelle CRAO, in quanto la perdita visiva è severa, mentre nelle BRAO il difetto del campo visivo tende a stabilizzarsi nel tempo, il buon funzionamento dell’occhio controlaterale e i movimenti del capo compensano il deficit, il recupero dell’acuità visiva dipende dal coinvolgimento maculare.
Terapia
L’occlusione arteriosa retinica è una situazione di emergenza in quanto la perdita della visione è irreversibile ed è in relazione con il tempo che intercorre tra l’occlusione dell’arteria e la sua riperfusione. Tuttavia, non vi sono ancora oggi terapie che abbiano mostrato una chiara efficacia. Possono essere eseguite alcune manovre finalizzate a ridurre la pressione oculare allo scopo di mobilizzare l’eventuale embolo presente come: il massaggio oculare eseguito tramite una lente a tre specchi (usata comunemente per esaminare il fondo oculare e l’angolo irido-corneale) che viene posta a contattato con l’occhio, la paracentesi della camera anteriore e aspirazione di 0,1-0,2 ml di umor acqueo, utilizzo di farmaci ipotonizzanti. La rirespirazione in un sacchetto di carta, che aumenta l’anidride carbonica nel sangue, provoca vasodilatazione con possibile rimozione dell’embolo. Sembra avere un buon effetto la respirazione di una miscela di ossigeno al 95% e anidride carbonica al 5% per un possibile effetto sul ritardo dell’ischemia e induzione della vasodilatazione. Vengono usati anche farmaci fibrinolitici e anticoagulanti.
Prevenzione
È importante ridurre il rischio di insorgenza di occlusioni arteriose retiniche agendo sui fattori di rischio modificabili come il controllo della pressione sanguigna, del diabete e del colesterolo, oltre che assumere uno stile di vita sano controllando alimentazione ed eseguendo regolare attività fisica. Il paziente affetto da occlusione arteriosa retinica dovrà sottoporsi a controlli presso altri specialisti per valutare la presenza di questi fattori di rischio, soprattutto per scongiurare il verificarsi di altre patologie come ictus cerebrale e infarto cardiaco.
OCCLUSIONI VENOSE RETINICHE
Le occlusioni venose retiniche sono un gruppo eterogeneo di malattie vascolari della retina che possono compromettere l’acuità visiva anche in modo severo.
La causa è l’occlusione di una vena della retina dovuta al blocco della circolazione da parte di un trombo, questo può provocare la formazione di emorragie retiniche, la comparsa di edema maculare e di aree ischemiche (aree scarsamente irrorate).
Le occlusioni retiniche sono patologie che interessano in generale persone con età maggiore di 60 anni senza differenze di sesso. I fattori di rischio predisponenti sono comuni ad altre patologie vascolari come ictus e ischemie cardiache, in particolare tra i principali vi sono l’ipertensione arteriosa, il diabete mellito, iperlipidemia, disturbi della coagulazione e patologie che causano aumento della viscosità del sangue come il mieloma multiplo e le leucemie. Vi sono anche fattori oculari che possono predisporre a occlusioni venose come la presenza di glaucoma, traumi oculari, vasculite retinica, occlusione dell’arteria centrale, malformazioni artero-venose.
Le occlusioni venose vengono classificate in base alla vena ostruita in: occlusioni venose centrali retiniche (CRVO central retinal vein occlusion) quando è la vena centrale della retina a essere interessata, occlusioni venose di branca retinica (BRVO branch retinal vein occlusion) quando a essere bloccato è un ramo di essa.
Occlusioni venose di branca retinica
Le BRVO sono causate dall’ispessimento e indurimento di un’arteriola retinica associato a compressione di una vena in corrispondenza di un incrocio artero-venoso, questo provoca la formazione di un moto turbolento all’interno della vena e la formazione di un trombo che interrompe il passaggio di sangue producendo aumento della pressione all’interno dei capillari. Questo provoca la formazione di emorragie, diffusione di liquido nello spessore retinico e ischemia per costrizione arteriosa secondaria all’assenza di perfusione del circolo capillare.
Le BRVO esordiscono con un calo improvviso, monolaterale della vista se coinvolgono la regione centrale della retina (macula), quando sono periferiche possono essere asintomatiche.
Per la diagnosi è necessaria una visita oculistica con valutazione del fondo oculare dopo dilatazione pupillare completata dalla fluorangiografia (FAG) che permette una migliore caratterizzazione dell’entità dell’occlusione, della presenza di edema e aree ischemiche. La tomografia a coerenza ottica (OCT) è utile per quantificare l’edema maculare e per seguire il paziente durante le visite di controllo.
Occlusioni venose centrali retiniche
Le CRVO colpiscono la vena centrale a livello della lamina cribrosa, l’occlusione provoca aumento della pressione venosa e capillare con conseguente ristagno di sangue all’interno dei vasi, questo comporta una riduzione dell’apporto di ossigeno alle cellule retiniche e lesione dell’endotelio capillare con accumulo di prodotti di scarto.
Le CRVO si dividono in non ischemiche e ischemiche.
Le forme non ischemiche sono le più frequenti, si presentano con calo della vista improvviso monoculare. All’esame del fondo oculare si evidenziano dilatazioni e tortuosità dell’intero albero venoso, emorragie di diversa dimensione, edema della papilla ottica e della macula. La FAG è necessaria per valutare la perfusione capillare residua.
Le forme ischemiche sono meno comuni, ma la prognosi è spesso sfavorevole, già alla diagnosi il paziente in genere si presenta con marcata riduzione della vista, tanto da non vedere le lettere sul tabellone. Al fondo oculare si evidenzia marcata ischemia del nervo ottico ed emorragie diffuse a livello maculare, oltre a marcata tortuosità e dilatazione venosa.
Complicanze
Le occlusioni venose possono essere complicate dalla formazione di neovasi a partenza dalle aree ischemiche e alla loro progressione fino a provocare un glaucoma neovascolare, con aumento della pressione oculare e compromissione della vista fino alla cecità.
Queste complicanze sono più comuni nelle CRVO e in genere insorgono tra 6-12 mesi dall’esordio dei sintomi.
Terapia
La terapia delle occlusioni venose deve essere improntata sulla riduzione dell’edema maculare per migliorare l’acuità visiva e la prevenzione delle complicanze.
Le iniezioni intravitreali di desametasone a lento rilascio permettono una buona riduzione dell’edema maculare, ma hanno durata limitata di circa 4 mesi e possono essere associate ad aumento della pressione intraoculare e all’insorgenza precoce di cataratta, il loro uso nel lungo periodo è tutt’ora controverso.
Gli inibitori del fattore di crescita dell’endotelio vascolare (anti VEGF) quali Ranibizumab e Aflibercept vengono ora utilizzati sia per il loro effetto antiedemigeno sia per la prevenzione della formazione di neovasi, ma necessitano iniezioni mensili ripetute.
Il trattamento laser può essere di due tipi: la fotocoagulazione panretinica che provoca la formazione di cicatrici a livello delle aree ischemiche periferiche ed è finalizzato a prevenire o a far regredire i neovasi; la griglia maculare si avvale di spots laser a bassa energia effettuati al centro della retina e consente la riduzione dell’edema maculare nelle forme senza ischemia a livello centrale.
Prevenzione
La prevenzione primaria delle occlusioni venose retiniche deve essere improntata sull’identificazione dei fattori di rischio e l’attuazione di stili di vita e terapie improntate sulla loro riduzione.
La prevenzione secondaria si basa sull’identificazione delle cause che hanno portato all’occlusione venosa retinica e il loro trattamento in modo da evitare l’insorgenza di altre patologie vascolari sistemiche che condividono gli stessi fattori predisponenti.
Pertanto, l’approccio multidisciplinare, che quindi coinvolga non solo l’oculista ma altri specialisti (cardiologi, internisti, ematologi), è fondamentale per l’adeguato approccio preventivo e percorso terapeutico.
OCT
L'OCT è una delle metodiche strumentali più recenti impiegate per la diagnosi delle patologie oculari; inizialmente nata esclusivamente per lo studio della retina (macula e polo posteriore), i suoi campi d’applicazione sono stati estesi anche alla valutazione del nervo ottico e della cornea.
L'OCT retinico esegue una scansione topografica della macula e nervo ottico fondamentale per la diagnosi e il follow-up delle patologie maculari e del glaucoma fornendo un’analisi morfologica e quantitativa mediante la ricostruzione di mappe volumetriche.
E' un esame non invasivo, molto ripetibile, che non richiede l’iniezione di mezzo di contrasto; unico limite è la necessità di una buona trasparenza dei mezzi diottrici per ottenere immagini di buona qualità.
Indicato anche per lo screening delle patologie maculari, le indicazioni principali sono rappresentate dallo studio della maculopatia senile, miopica, edema maculare cistoide nella retinopatia diabetica e sindromi dell’interfaccia vitreoretinica (membrane epiretiniche, foro maculare, ecc...).
L'esame OCT consente una diagnosi precoce e rapida, riducendo in molti casi le indicazioni all’esecuzione di esami più invasivi quali la fluorangiografia.
Ulteriore indicazione all’OCT è lo studio della testa del nervo ottico (papilla); mediante tale analisi è possibile riconoscere delle alterazioni patologiche (parziale perdita delle fibre nervose, aumento dell’escavazione fisiologica, ecc.) che in alcuni casi consento la diagnosi precoce del glaucoma, ancor prima che siano comparsi i danni funzionali al campo visivo.
In aggiunta, alcune nuove macchine sono state dotate di lenti addizionali in grado di spostare il fuoco della scansione anteriormente ed eseguire un’analisi corneale; in tale modo è possibile ottenere dati morfologici e ricostruzione dello spessore corneale.
PUCKER MACULARE

RETINA - MER IV STADIO
Il Pucker maculare è una patologia che si sviluppa nella zona centrale al confine (interfaccia) tra il corpo vitreo e la macula. Dal punto di vista fisiopatologico si caratterizza per la presenza di una sottile membrana che si sviluppa a livello maculare provocando la progressiva distorsione degli strati retinici più interni.
Identificata con diversi nomi (membrana pre-retinica, pucker maculare, sindrome dell'interfaccia vitreoretinica, maculopatia a cellophane), è provocata dalla proliferazione di alcuni tipi di cellule retiniche che causano l’ispessimento e la successiva contrazione della membrana limitante interna (il più interno degli strati retinici) e degli strati retinici sottostanti. Tale processo può portare alla progressiva deformazione della neuroretina con insorgenza di edema intraretinico.
EZIOLOGIA
Nella maggior parte dei casi insorgono senza associazione con altre malattie, nel qual caso vengono chiamate membrane idiopatiche. Possono comunque essere secondarie ad altre problematiche oculari, le rotture retiniche, il distacco retinico, le malattie oculari infiammatorie e vascolari e le emorragie vitreali.
SINTOMATOLOGIA
I sintomi sono rappresentati da una progressiva distorsione delle immagini (metamorfopsia) con la comparsa di una macchia grigia centrale (scotoma). L’alterazione del visus è comunque molto variabile, così come la sua progressione. La distorsione delle immagini è il sintomo più comune e per la sua diagnosi è spesso impiegato il test di Amsler, utile anche per la valutazione casalinga della progressione della patologia.
DIAGNOSI
L’esame del fondo oculare è in genere sufficiente per porre la diagnosi;
la tomografia a coerenza ottica (OCT) è ad ogni modo l’esame d’elezione in questa patologia, consentendo sia la conferma diagnostica, sia la possibilità di monitorare l’evoluzione e gli eventuali risultati della chirurgia maculare.
TERAPIA
Nella maggior parte dei pazienti non è necessario alcun trattamento, poiché di solito la distorsione e la diminuzione visiva sono minime e tollerabili. In alcuni casi, tuttavia, i sintomi possono essere importanti e invalidanti, con problemi alla lettura o alla guida. In questi casi la terapia è chirurgica, mediante intervento di asportazione del corpo vitreo (vitrectomia) e rimozione meccanica (peeling) della membrana.
RETINOPATIA DIABETICA
La retinopatia diabetica è la più importante complicanza oculare del diabete mellito e la prima causa di cecità legale nella popolazione di età lavorativa. La retinopatia diabetica è causata da un danno ai vasi sanguigni che si trovano sulla retina, il tessuto fotosensibile dell’occhio. Livelli elevati di glucosio nel sangue provocano alterazioni ai vasi sanguigni (arterie, vene, capillari). La retina è un organo riccamente vascolarizzato e con una elevata richiesta di ossigeno, questo fa sì che sia uno dei primi organi a soffrire di tali alterazioni.
La retinopatia diabetica è classificata in base alla sua gravità in retinopatia diabetica non proliferante (lieve, moderata e severa) e retinopatia diabetica proliferante (a basso o alto rischio).
Nelle forme iniziali i primi segni che si osservano sono dovuti a danni a vasi retinici con la formazione di microaneurismi e microemorragie. Successivamente, l’avanzare della sofferenza dei vasi provoca la loro chiusura con conseguente formazione di aree ischemiche, in particolare nelle zone più periferiche della retina. Da queste aree ischemiche si liberano fattori che promuovono la formazione di nuovi vasi e l’avanzare della patologia nella forma proliferante. I vasi neoformati non possiedono una struttura adeguata e possono facilmente rompersi provocando emorragie pre-retiniche ed endovitreali con possibili distacchi retinici secondari.
A livello della macula, la zona della retina più importante per la visione, si può accumulare del liquido (edema maculare cistoide) comportando abbassamento e annebbiamento della vista.
Il rischio di sviluppare la retinopatia diabetica aumenta con la durata del diabete, dati epidemiologici affermano che almeno il 30% della popolazione diabetica ne sia affetta e ogni anno l’1% sviluppa le forme gravi. I fattori di rischio associati alla comparsa di retinopatia diabetica e la sua evoluzione sono: la durata del diabete, cattivo controllo glicemico e ipertensione arteriosa concomitante.
Sintomi
Negli stadi iniziali della retinopatia diabetica il paziente può non avvertire nessun sintomo perché i danni si verificano prima nelle zone periferiche della retina, per questo è importante che i pazienti affetti da diabete mellito eseguano visite oculiste periodiche.
Successivamente, con il coinvolgimento della macula, il paziente può avvertire un calo progressivo della vista con senso di annebbiamento. Spesso sono presenti fluttuazioni circadiane della visione legate all’instabilità dei valori ematici della glicemia, soprattutto in pazienti con scarso controllo metabolico. Negli stadi più avanzati della retinopatia diabetica si possono sviluppare complicanze gravi come il distacco di retina trazionale e il glaucoma neovascolare, condizioni che possono condurre a cecità.
Diagnosi
I pazienti diabetici devono sottoporsi a visite oculistiche periodiche per una diagnosi precoce, l’esame del fondo oculare, eseguito tramite dilatazione pupillare, permette la diagnosi e la stadiazione della retinopatia diabetica. La fluorangiografia (FAG) permette una miglior valutazione delle aree ischemiche per la pianificazione del trattamento laser. La tomografia a coerenza ottica (OCT) permette la valutazione della zona maculare evidenziando l’edema maculare cistoide, utile per l’impostazione della terapia e per il follow up dei pazienti.
Terapia
Il controllo glicemico è l’arma più efficace per ridurre la frequenza di comparsa o di aggravamento della retinopatia diabetica. In caso di progressione verso forme severe vi sono diverse alternative terapeutiche a seconda della situazione specifica.
Trattamenti laser mirati per le forme edematose e per ridurre le complicanze delle forme proliferanti con neovasi. Vi sono diversi tipi di trattamento laser. La fotocoagulazione “panretinica” (tutta la periferia della retina) si esegue nelle regioni ischemiche periferiche per prevenire la formazione di neovasi o indurre la regressione di quelli preesistenti con lo scopo di ridurre il rischio di complicanze gravi, come l’emovitreo (emorragia del vitreo) e il distacco di retina. Il “trattamento focale” (griglia maculare) viene eseguito nella zona centrale della retina per ridurre l’edema maculare. Laser micropulsato sottosoglia è un tipo particolare di laser che viene eseguito quando l’edema maculare non è particolarmente severo (<400 micron) ma comporta riduzione dell’acuità visiva. Questi trattamenti laser hanno l’obiettivo di ripristinare un’acuità visiva il più soddisfacente possibile.
Iniezioni intravitreali di farmaci che inibiscono il fattore di crescita vascolare (anti- VEGF) utili per far regredire i neovasi nelle forme in cui il trattamento laser non è sufficiente e nelle forme con edema maculare cistoide (>400 micron).
Impianto intravitreale di desametasone a lento rilascio, corticosteroide che viene utilizzato nelle forme con edema maculare.
Chirurgia vitreo-retinica viene eseguita nei casi più gravi come distacco retinico trazionale o retinopatia diabetica proliferante con emorragie vitreali recidivanti.
STRABISMO
Lo strabismo è la condizione di disallineamento degli assi visivi dei due occhi. Ciò comporta l'insorgenza di percezioni sensoriali alterate con perdita della visione binoculare che normalmente permette di percepire come uniche le immagini provenienti dai due occhi.
È una malattia relativamente comune che riguarda circa il 4% della popolazione e può manifestarsi a qualunque età.
Nei bambini, qualora non venga diagnosticato in tempo utile può determinare la perdita progressiva della propria capacità visiva (ambliopia). La comparsa di strabismo in età̀ adulta provoca, invece, una visione doppia (diplopia), poiché́ il cervello è ormai abituato a ricevere immagini dai due occhi e non può più ignorare l’immagine proveniente dall’occhio deviato.
CAUSE
Lo strabismo può̀ essere ereditario o secondario ad anomalie oculari; le cause variano in funzione dell’età di insorgenza.
Nel bambino, quando c’è un impedimento alla visione di un occhio, il cervello tende a escluderlo; ciò può verificarsi per problemi refrattivi (quali miopia e, soprattutto, ipermetropia e astigmatismo) o per una cataratta congenita. Altra comune causa di strabismo è la visione ridotta in un occhio (ambliopia) che impedisce la normale collaborazione tra i due occhi, generando di solito uno strabismo divergente. Infatti, se il bambino vede meglio con un occhio, il cervello ignora l’immagine dell’occhio che vede meno (soppressione), che di conseguenza diventa pigro: non venendo più utilizzato diventa strabico.
Nell'adulto, invece, si possono manifestare forme di strabismo da collegarsi a fenomeni di paralisi dei muscoli oculomotori o si può evidenziare una forma di strabismo latente non più compensato. Tra le cause di paralisi vi possono essere traumi cranici, malattie vascolari, malattie infettive, degenerative del sistema nervoso centrale e diabete.
SINTOMI
I possibili sintomi, soggettivi, dello strabismo possono essere: mal di testa (cefalea); stanchezza visiva (che può accentuarsi nella visione da vicino); bruciore; fotofobia (fastidio alla luce); talvolta inclinazione del capo; aggrottamento delle sopracciglia, visione doppia (diplopia), sensazione vertiginosa e difficoltà di orientamento.
CLASSIFICAZIONE
Lo strabismo viene distinto a seconda della deviazione o della direzione in cui guarda l’occhio. Distinguiamo lo strabismo concomitante, caratterizzato da una deviazione uguale in tutte le posizioni di sguardo, e lo strabismo incomitante (paralitico). In quest’ultimo al contrario, la deviazione varia a seconda della posizione degli occhi: è maggiore dove agisce il muscolo oculare deficitario. Può essere, inoltre, convergente (esotropia), quando l’occhio è deviato verso l’interno, o divergente (exotropia), verso l’esterno, o ancora verticale (ipertropia), nel caso in cui l’occhio appare deviato verso l’alto o ipotropia, verso il basso.
Lo strabismo concomitante è, in genere, quello più frequente nell’età infantile e dipende da anomalie dei fattori nervosi che regolano la posizione degli occhi: ogni muscolo preso singolarmente è normalmente funzionante, ma viene alterato l’equilibrio sotteso al meccanismo della visione binoculare.
Se quest’alterazione non è costante e si manifesta solo in determinate condizioni si è in presenza di eteroforia o strabismo latente; se, invece, l’alterazione è ben visibile in qualsiasi condizione si è in presenza di eterotropia o strabismo manifesto.
Lo strabismo incomitante è, generalmente, quello più frequente nell’adulto. Infatti, in presenza di una paralisi dei muscoli dell’occhio, viene persa la capacità di muovere i due occhi contemporaneamente e ciò provoca una diplopia (visione doppia). La diplopia aumenta quando si guarda dalla parte del muscolo paralizzato: i pazienti tendono a ruotare il capo dalla parte opposta per ridurre la visione doppia presentando, così, un torcicollo oculare oppure a tenere un occhio chiuso.
VALUTAZIONE CLINICA
Gli accertamenti utili per la diagnosi di strabismo sono la visita oculistica e la valutazione ortottica con studio della motilità oculare durante le quali si analizzeranno diversi aspetti:
-
ANAMNESI:
-
Età di insorgenza: Più l’età di insorgenza è precoce, più è probabile si presenti la necessità di un intervento chirurgico. Più è tardiva, più è probabile che si tratti di una forma con componente accomodativa (che insorge prevalentemente tra i 18 e 36 mesi).
-
Possono segnalare una forma di strabismo latente non più compensato o il riscontro di una condizione acquisita recentemente, di solito paretica.
-
Salute generale o problemi di sviluppo: nelle paralisi cerebrali infantili vi è una maggiore incidenza di strabismo. Nei pazienti più anziani condizioni di salute scadenti o stress possono provocare decompensazione mentre nella paresi acquisita i pazienti possono presentare fattori associati o causali (traumi, malattie neurologiche, diabete)
-
Anamnesi familiare: lo strabismo è spesso familiare, sebbene non sia determinato un quadro ereditario definito.
-
ACUITÀ VISIVA
Nei bambini in età preverbale:
-
Capacità di fissare e seguire un oggetto: può essere valutata utilizzando un oggetto che susciti interesse e di colore vivace. Tale metodo indica se l’attenzione visiva del bambino è presente.
-
Comportamento di fissazione: può essere utilizzato per stabilire la preferenza unilaterale in presenza di uno strabismo evidente. Occludendo l’occhio dominante che fissa un oggetto si promuove la fissazione con l’occhio deviato. Dopodiché viene scoperto l’occhio e si valuta la capacità di mantenere la fissazione: se questa torna all’occhio appena scoperto è probabile una compromissione dell’acuità visiva dell’occhio deviato; se viene mantenuta con la chiusura dell’occhio appena scoperto l’acuità è probabilmente buona; se il paziente mantiene la fissazione l’acuità è pressoché uguale nei due occhi.
Nei bambini di età superiore a due anni
-Figure di Kay (a): i bambini hanno una padronanza di linguaggio sufficiente per essere sottoposti ad un test sul riconoscimento di immagini.
-Test di affollamento di Keeler (b): all’età di 3 anni la maggior parte dei bambini è in grado di riconoscere le lettere in un ottotipo a caratteri singoli.
-Tavole EDTRS (dopo i 3 anni)
-
TEST PER LA STEREOPSI
-Test di Lang: le figure sono viste alternativamente da ciascun occhio perché gli stimoli presentati sono stampati attraverso cilindri orientati in modo che ciascuno sia percepito da un occhio. La disposizione dei punti crea disparità e al paziente viene chiesto di individuare semplici figure come una stella sulla cartolina.
-
MISURAZIONE DELLA DEVIAZIONE
-Cover- Uncover test: Fondamentale per tutte le forme di strabismo, differenzia lo strabismo latente da quello manifesto. Consente di individuare direzione e dimensioni approssimative delle deviazioni (tramite l’uso dei prismi).
COME SI RISOLVE?
Le opzioni terapeutiche sono diverse e finalizzate, prima di tutto, a ripristinare una buona qualità visiva e secondariamente ad allineare correttamente gli occhi. Esse variano in base alle cause e alle caratteristiche dello strabismo, comprendendo:
-Il bendaggio dell’occhio che vede bene al fine di incoraggiare quello “pigro” (che vede meno) a lavorare di più, migliorando così la capacità visiva.
-È importante eseguire un’attenta misurazione della vista con l’instillazione di un collirio cicloplegico che, bloccando l’accomodazione, permette di correggere alcune forme di strabismo con gli occhiali, come in caso, ad esempio, di strabismi convergenti causati da ipermetropie elevate.
-Gli esercizi oculari ortottici possono essere utili per migliorare la funzionalità dei muscoli oculari e per correggere i deficit di convergenza e infine
-Il trattamento delle patologie scatenanti. Quando lo strabismo insorge, invece, in età̀ adulta, come conseguenza di patologie sistemiche quali diabete o ipertensione, la terapia è la cura di queste cause scatenanti; la risoluzione dello strabismo in questi casi può essere spontanea.
Qualora la terapia medica non fosse sufficiente a ripristinare il normale allineamento degli occhi, si può ricorrere alla chirurgia.
I principali scopi della chirurgia dello strabismo sono il ripristino o mantenimento di una visione binoculare, l’eliminazione o riduzione della diplopia, la correzione di una posizione anomala del capo e il ripristino di un normale aspetto estetico. Nel bambino l'intervento può avvenire non prima dei due-tre anni di vita, si svolge in anestesia generale. Nei giovani e negli adulti, viene proposta l'anestesia locale, in modo da ottenere una collaborazione del paziente durante l'intervento ed il vantaggio di una rapida dimissione.
L’intervento consiste nell’agire su uno o più muscoli extraoculari, cioè quei muscoli incaricati di muovere l'occhio nelle varie direzioni, in modo da metter gli occhi il più possibile in asse. Le tre principali procedure chirurgiche sono:
-
Indebolimento: intervento di recessione che diminuisce la forza effettiva di azione di un muscolo spostando indietro la sua inserzione sulla sclera
-
Rinforzo: intervento di resezione, che comporta l’accorciamento di un muscolo al fine di aumentarne il potere trazionale.
-
Trasposizione: finalizzato al cambiamento di direzione dell’azione di un muscolo. Si riferisce alla rilocalizzazione di uno o più muscoli extraoculari per sostituire un muscolo assente o con grave deficit.
Nei giorni che seguono l'intervento gli occhi sono rossi. Possono presentarsi un disturbo visivo passeggero, lacrimazione, bruciore, prurito e a volte mal di testa. Tutti questi segni spariscono solitamente con un trattamento locale (gocce o pomata). La cicatrizzazione completa della congiuntiva richiede più giorni.
Le complicanze della chirurgia dello strabismo sono rare. È possibile la comparsa in alcune persone operate di una diplopia (visione doppia) in modo passeggero. Spesso questo disturbo scompare spontaneamente ma può̀ a volte rendere necessario un trattamento complementare, anche chirurgico.
La rottura di un muscolo anormale o la perforazione della parete dell'occhio molto sottile sono le complicazioni eccezionali e imprevedibili legate alle condizioni anatomiche anormali che possono rendere necessario un trattamento chirurgico complementare.
ALLERGIE OCULARI
La prevalenza delle malattie allergiche è notevolmente aumentata negli ultimi anni; si stima, infatti, che la percentuale di soggetti affetti da allergie sia il 20-40% della popolazione e che i sintomi oculari siano presenti nel 40-60% degli individui allergici.
Le allergie oculari sono patologie a carattere immunitario, che colpiscono la congiuntiva e la cornea; le forme più comuni sono sicuramente dovute al polline (specialmente in primavera e nelle stagioni più calde) e acari, mentre meno comuni sono forme legate a farmaci, pelo di animali, cosmetici o all’uso di lenti a contatto.
Sono distinte due forme principali di congiuntivite in base all’esordio dei sintomi:
-
Acuta: i sintomi regrediscono in un tempo relativamente breve.
-
Cronica: i sintomi sono meno irruenti ma tendono a persistere per lunghi periodi.
La classificazione basata sulla causa scatenante comprende, invece, le seguenti forme cliniche:
-
Congiuntivite allergica stagionale e perenne;
-
Cheratocongiuntivite primaverile;
-
Cheratocongiuntivite atopica;
-
Congiuntivite gigantopapillare;
-
Blefarocongiuntivite da contatto.
La struttura oculare più colpita è la congiuntiva, che presenta in genere segni di rigonfiamento (edema), rossore più o meno marcato (iperemia), secrezione sierosa o siero-mucosa, follicoli ed ipertrofia papillare, mentre spesso la cornea è coinvolta nelle forme più severe, croniche o come complicanza.
In tali condizioni, oltre ai sintomi comuni quali rossore, prurito, fotofobia, lacrimazione e bruciore può essere presente un calo del visus legato alla presenza di ulcere (dette a “scudo”), noduli a livello del limbus sclero- corneale, cheratite puntata o cicatrici sulla superficie anteriore della cornea.
È frequente una contemporanea rinite. Molti pazienti soffrono di altre patologie atopiche, come eczema, rinite allergica ed asma.
La diagnosi è essenzialmente clinica, ma possono essere di supporto alcuni test di laboratorio, test cutanei, dosaggi di Immunoglobuline e test di provocazione congiuntivale.
La prima misura preventiva è evitare l’esposizione all’allergene mentre l’utilizzo di sostituti lacrimali può essere utile sia per rinforzare la barriera protettiva che per diluire allergeni e mediatori dell’infiammazione.
La terapia farmacologica deve tener conto del quadro clinico generale, della durata della sintomatologia, dell’entità dell’infiammazione congiuntivale e di eventuali sintomi sistemici allergici.
Essa è rappresentata dalla rimozione dell’antigene scatenante (quando possibile) e dalla somministrazione di farmaci antistaminici e cortisonici topici (in collirio); solo in casi severi è necessario instaurare anche terapia sistemica.
CHIRURGIA REFRATTIVA
La chirurgia refrattiva comprende tutte quelle tecniche chirurgiche e para-chirurgiche che hanno lo scopo di modificare il potere refrattivo di un occhio al fine di ottenere una migliore acuità visiva senza l’ausilio di occhiali o lenti a contatto, annullando o riducendo i difetti di vista.
La correzione refrattiva mediante “Laser ad Eccimeri” è sicuramente la procedura più adottata per il trattamento definitivo dei difetti di vista, ma non è l’unica; attualmente sono molto usate anche le procedure che sfruttano il “Laser a Femtosecondi” (o Femtolaser).
Il Laser ad Eccimeri è un tipo di laser che è in grado di asportare molecole dalla superficie corneale con estrema precisione attraverso un meccanismo di vaporizzazione istantanea chiamato fotoablazione, generando un rimodellamento della cornea, senza creare nessun danno nelle zone adiacenti la parte fotoablata.
Il Laser a Femtosecondi utilizza una luce infrarossa con impulsi della grandezza di pochi micron e di brevissima durata che può essere focalizzata a diverse profondità nell’occhio ed è in grado, in questo modo, di ‘tagliare’ i tessuti nel punto desiderato; il fascio di luce laser per la sua elevatissima velocità produce bassa energia, non arrecando danni all’interno dell’occhio. Con quest’ultima tipologia di laser, l’oculista, a seconda delle esigenze del paziente e dell’entità del difetto da correggere, può decidere se effettuare la tecnica “Femtolasik” o la tecnica “Smile”.
Il principio su cui si basa la chirurgia refrattiva è la modifica della curvatura della cornea in modo tale da ripristinare la corretta acuità visiva facendo sì che i raggi luminosi siano focalizzati sulla retina; questa tecnica induce modificazioni nella curvatura corneale atte a cambiare il potere diottrico della cornea. In particolare il laser “appiattisce” la cornea nella sua zona centrale per la correzione della miopia, mentre la “incurva”, aumentandone il potere, in caso d’ipermetropia. In presenza di astigmatismo, invece, la ‘appiattisce’ o ‘incurva’ su un meridiano specifico.
Non tutti i pazienti sono candidati a questo tipo di chirurgia; la selezione del paziente è un momento fondamentale per l’ottimale riuscita di un intervento di chirurgia refrattiva, in quanto costituisce il primo passo per ridurre le possibilità di complicanze e/o di scarsi risultati funzionali.
I soggetti potenzialmente interessati sono tutti coloro che presentano un vizio di refrazione in uno o entrambi gli occhi. Poiché esistono anche delle controindicazioni all’intervento, è necessaria un’accurata visita specialistica durante la quale si verificheranno le necessità e le aspettative del paziente, si illustrerà il programma operatorio e le varie fasi dell’intervento e si discuterà sul possibile risultato ottenibile.
Una corretta valutazione preoperatoria consiste nell’esecuzione degli esami normalmente effettuati durante una visita oculistica di routine (refrazione in miosi e in cicloplegia, oftalmometria, esame biomicroscopico, test di funzionalità lacrimale, tonometria, esame del segmento posteriore) e di esami più specifici rispetto alla procedura refrattiva (topografia corneale/ tomografia corneale, aberrometria, pupillometria, pachimetria corneale, microscopia endoteliale-, esame ortottico).
La chirurgia refrattiva mediante laser costituisce uno strumento valido e sicuro per la correzione dei difetti visivi.
PROCEDURE
Le tecniche di chirurgia refrattiva disponibili sono diverse; non esiste una tecnica migliore dell’altra, sarà l’oculista a scegliere la tecnica più corretta in base al tipo di difetto, alla conformazione dell’occhio o al risultato che si vuole raggiungere. Le tecniche più impiegate attualmente sono: la PRK (Photorefractive Keratectomy), la LASIK (Laser-Assisted In-Situ Keratomileusis) e la SMILE (SMall Incision Lenticule Extraction).
PRK
Si tratta di una procedura eseguita mediante un Laser ad Eccimeri che viene guidato e modulato da un computer che indirizza il fascio luminoso sulla superficie corneale.
Il trattamento viene eseguito sulla cornea dopo aver rimosso l’epitelio, che ne rappresenta la parte più esterna; il raggio laser asporta, in pochi secondi, tessuto in quantità di alcuni millesimi di millimetro per spot, con elevatissima precisione e senza creare danno al tessuto circostante. Il raggio laser è così in grado di modellare il profilo della cornea, appiattendone o aumentandone la curvatura della zona ottica, permettendo la correzione del difetto visivo.
Questa tecnica trova indicazione per la correzione di miopia, ipermetropia e astigmatismo.
L’intervento viene eseguito in anestesia topica mediante l’instillazione di un collirio anestetico; la procedura è totalmente indolore, il paziente dovrà collaborare durante l’intervento osservando delle mire luminose. L’intervento ha una durata di circa 15 minuti, al termine del quale verrà applicata una lente a contatto e prescritta una terapia a base di colliri; l’occhio operato non ha bisogno di bendaggio.
Nelle prime 12-24 ore dopo l’intervento il paziente potrà avvertire fastidio oculare, bruciore, lacrimazione o gonfiore; questo quadro sintomatologico potrà essere controllato con un mirato trattamento farmacologico antinfiammatorio e antalgico.
La procedura è rapida, precisa, di semplice esecuzione e sicura. Il recupero della vista avviene in alcuni giorni e la stabilizzazione visiva definitiva può richiedere alcuni mesi.
FEMTOLASIK
La FEMTOLASIK è una procedura refrattiva che si avvale dell’utilizzo di due differenti laser, quello ad Eccimeri e quello a Femtosecondi.
L’intervento viene eseguito in anestesia topica attraverso l’instillazione di specifici colliri.
Il trattamento consta di due fasi: la prima fase prevede la creazione di un lembo di tessuto corneale mediante il Femtolaser; successivamente il lembo viene ribaltato esponendo gli strati più interni della cornea sui quali andrà ad agire il laser ad Eccimeri.
Al termine dell’intervento il lembo corneale viene riposizionato in sede, dove si risalda spontaneamente durante il processo di guarigione.
La procedura ha una durata complessiva di circa 10 minuti, al termine della quale non sarà necessario applicare una lente a contatto né effettuare un bendaggio, al paziente verrà prescritta una terapia a base di colliri.
Questa tecnica trova indicazione per la correzione di miopia, ipermetropia e astigmatismo.
La FEMTOLASIK consente un rapido recupero visivo ed i pazienti, in genere, lamentano un lieve discomfort oculare postoperatorio senza disturbi o dolori particolari.
Sebbene sia considerata una procedura sicura ed efficace, la FEMTOLASIK presenta un più alto tasso di complicanze rispetto alla PRK.
SMILE
La SMILE è la tecnica refrattiva di più recente introduzione e si basa sull’utilizzo del solo laser a Femtosecondi; ad oggi è indicata esclusivamente per il trattamento della miopia e/o dell’astigmatismo miopico.
Si tratta, anche in questo caso, di un intervento indolore in cui il paziente viene anestetizzato attraverso l’instillazione di qualche goccia di collirio.
Il laser è utilizzato per la scolpitura di un lenticolo all’interno della cornea di dimensioni proporzionali al difetto refrattivo da correggere, successivamente, lo stesso laser crea una piccola incisione sulla superficie corneale attraverso la quale il chirurgo estrae il lenticolo precedentemente creato.
L’estrazione del lenticolo induce una modifica della forma della cornea con conseguente correzione della miopia.
L’incisione corneale si cicatrizza in poche ore, senza necessità di una sutura e il recupero visivo si realizza molto velocemente; non è necessario il posizionamento di lenti a contatto o bendaggio alla fine dell’intervento.
Si tratta di una tecnica rapida e sicura gravata da poche complicanze.
IMPIANTO DI IOL FACHICA
La IOL fachica è una lente artificiale che viene posizionata all’interno dell’occhio correggendo il difetto visivo del paziente.
L’intervento, in genere, viene effettuato in anestesia topica attraverso l’utilizzo di colliri anestetici e prevede il mantenimento del cristallino naturale e l’impianto della lente artificiale al davanti di quest’ultimo, ovverosia nel segmento anteriore.
L’impianto di IOL fachica rappresenta una valida alternativa alla chirurgia refrattiva corneale con laser e trova applicazione in caso di difetti visivi di entità elevata o in caso di anomalie corneali che rappresentino una controindicazione alla chirurgia con laser.
La procedura risulta indolore, ma si tratta comunque di un intervento di chirurgia intraoculare che risulta quindi più complesso e invasivo rispetto a quelli eseguiti con laser e può avere complicanze maggiori.
DIFETTI DI VISTA
L’occhio è la sede dei processi iniziali della visione e, grazie al suo sistema di lenti (anche definite sistema diottrico o diottro oculare), forma sulla superficie retinica l’immagine degli oggetti dell’ambiente esterno.
Il sistema diottrico dell’occhio umano si compone di diverse strutture, le principali sono la cornea e il cristallino.
La cornea, trasparente e avascolare, rappresenta la prima lente che la luce incontra nel suo percorso ed è, inoltre, la lente dal potere maggiore del sistema ottico oculare.
Il cristallino è una lente situata tra l’iride e la retina la cui caratteristica principale è quella di poter modificare rapidamente il suo potere diottrico consentendo la messa a fuoco degli oggetti lontani e vicini; tale processo è definito “accomodazione”. Questa capacità diminuisce progressivamente dopo i quarant’anni a causa del fisiologico processo d’invecchiamento del cristallino, portando alla comparsa di “presbiopia”, la quale è caratterizzata da una progressiva difficoltà di messa a fuoco degli oggetti vicini (es. leggere il giornale).
L’occhio normale o emmetrope consente alle immagini esterne di focalizzarsi sulla retina, in altre parole grazie ai mezzi diottrici i raggi luminosi vanno a fuoco direttamente sulla retina, permettendo una visione nitida.
In condizioni anormali o di ametropia i raggi luminosi provenienti dall’esterno non sono messi perfettamente a fuoco sulla retina dando luogo, così, a immagini sfocate.
I più comuni difetti visivi sono: miopia, ipermetropia e astigmatismo.
Nell’occhio miope i raggi luminosi cadono davanti alla retina; ciò può essere dovuto a diversi fattori: una maggiore lunghezza dell'occhio, che rappresenta la causa più frequente, una curvatura corneale superiore alla norma o un aumento dell'indice di rifrazione del cristallino (cataratta).
In questi casi i raggi luminosi provenienti dall’esterno sono messi a fuoco anteriormente rispetto al piano retinico, formando un’immagine che sarà tanto più sfocata quanto maggiore è l’entità del difetto refrattivo; in particolare i pazienti lamenteranno di vedere male oggetti lontani.
La correzione della miopia si avvale dell’utilizzo di lenti sferiche concave (negative) che, sfruttando il fenomeno della divergenza dei raggi luminosi, permettono la messa a fuoco delle immagini a livello della retina.
Nell'occhio ipermetrope i raggi luminosi vanno a fuoco dietro la retina; ciò è causato, nella maggior parte dei casi, da una minore lunghezza dell'occhio o, meno frequentemente, da una curvatura corneale inferiore alla norma.
Tutto ciò comporta che i raggi luminosi provenienti dall’esterno siano messi a fuoco dietro la retina. Tale difetto provoca una cattiva visione degli oggetti sia vicini che lontani.
I soggetti giovani, attraverso uno sforzo dell’accomodazione, riescono (entro un certo limite) a correggere involontariamente il difetto, ottenendo una visione distinta; tale condizione, sebbene possa apparire vantaggiosa, è responsabile di disturbi definiti "astenopeici", tra i quali mal di testa, facile affaticamento nel lavoro ravvicinato, iperemia congiuntivale e dolenzia bulbare.
La correzione dell’ipermetropia si avvale dell’utilizzo di lenti sferiche convesse (positive) che, sfruttando il fenomeno della divergenza dei raggi luminosi, permettono la messa a fuoco delle immagini a livello della retina.
L’astigmatismo è un difetto refrattivo più complesso dei precedenti ed è causato, nella maggioranza dei casi, dalla presenza di una cornea di forma ovalare, anziché sferica. A causa di ciò, l’occhio non è più in grado di focalizzare i raggi luminosi in un singolo punto della retina, questo determina una visione distorta degli oggetti a tutte le distanze. I raggi luminosi, infatti, invece di cadere su un unico punto focale si disperdono su due linee focali disposte ad angolo retto, una anteriore ed una posteriore. L’astigmatismo si associa ai difetti sferici principali e può essere di tipo miopico, ipermetropico o misto (a seconda della posizione delle due linee focali rispetto al piano retinico).
CORREZIONE DIFETTI VISIVI
La correzione dei difetti visivi si effettua attraverso l’impiego di lenti a tempiale (occhiali) e lenti a contatto (LAC) oppure, in modo definitivo, mediante il ricorso alla chirurgia refrattiva.
Le lenti a tempiale rappresentano lo strumento più utilizzato per la correzione dei difetti visivi di grado lieve-moderato in quanto versatili ed economici; la loro efficacia e praticità, tuttavia, diminuisce all’aumentare del difetto refrattivo in quanto le aberrazioni prismatiche e ottiche indotte da lenti di elevato spessore penalizzano la qualità visiva del paziente.
Le lenti a contatto superano gran parte dei problemi connessi all’uso degli occhiali. Esse, inoltre, ampliano il campo visivo, lasciano maggior libertà di azione, ad esempio nelle attività sportive, e non incidono sull’aspetto estetico. Per contro il loro utilizzo deve essere limitato nel tempo perché, se usate a lungo, possono provocare disturbi del sistema lacrimale dando luogo a secchezza oculare o complicanze della superficie oculare; richiedono una manutenzione scrupolosa e controlli periodici per ridurre il rischio d’infezioni e di altre complicanze.